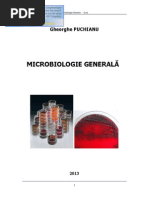

Power Point Microb Spec Biot
Încărcat de
Dima CebotariSubiecte abordate
- microflora cărnii,
- bacterii aerobe,
- bacterii halofile,
- bacterii de degradare,
- bacterii gram-pozitive,
- microorganisme saprofite,
- degradarea alimentelor,
- microorganisme patogene,
- bacterii anaerobe,
- bacterii de protecție
Power Point Microb Spec Biot
Încărcat de
Dima CebotariSubiecte abordate
- microflora cărnii,
- bacterii aerobe,
- bacterii halofile,
- bacterii de degradare,
- bacterii gram-pozitive,
- microorganisme saprofite,
- degradarea alimentelor,
- microorganisme patogene,
- bacterii anaerobe,
- bacterii de protecție
Microbiologie special
Specialitatea: Biotehnologii agricole
Prezint: [Link]. Rita Golban
Tema [Link] alimentelor
[Link] i semnificaia microorganismelor n alimente
Toate microorganismele ca i bacteriile, mucegaiurile i
drojdiile sunt diseminate universal n mediul nconjurtor,
prezente n cadrul general al reciclrii continue a
elementelor substanei vii.
Din sol i din ap, aceste microorganisme i croiesc
drum spre plante, n aer, praf, tractul intestinal al omului
i animalelor i napoi spre sol i ap unde ciclul
continu.
Fiecare gen pare s ocupe o ni mai mult sau mai puin
specific n natur i cunoaterea acestui fapt va permite
s prevedem prezena acestor microorganisme i n
alimente.
Din punct de vedere practic i relativ simplist
microorganismele din alimente se clasific n dou
categorii: microflora saprofit i microflora patogen.
Tema [Link] alimentelor
[Link] saprofit i patogen
Flora saprofit este alctuit din toate microorganismele pe care
alimentul le ntlnete n circuitul su, de la obinere pn la consumator
i care nu genereaz [Link] germeni, dei de provenien
ntmpltoare, snt mai mult sau mai puin caracteristici pentru fiecare
grup de alimente, pentru c un anumit grup de alimente tlnete de obicei
pe circuitul sau condiii aproximativ asemntoare.
Existena acestor microorganisme n numr prea mare este un indicator
al unor condiii de igien necorespunztoare i poate influena negativ
sntatea consumatorului prin produii de degradare enzimatic pe care
i realizeaz.
Microflora saprofit foarte variat care populeaz alimentele poate
provoca degradri i alterri care antreneaz modificri importante fizicochimice i nutritive ale produselor i care provoac frecvent mari pagube
economice.n plus , prin aciunea lor asupra substratului alimentar,
microorganismele obinuit nepatogene ajunse n condiii ecologice
adecvate oferite de alimente, pot genera descompunerea acestora prin
proteoliz, lipoliz i glucoliz, iar produii respectivi de putrefacie,
rncezire i fermentaie parial cunoscui n trecut sub termenul de
putrefacie, nu numai c modific prin aceast alterare proprietile
organoleptice, dar creaz serioase riscuri pentru sntatea
consumatorului.
Tema [Link] alimentelor
Flora saprofit , care se face vinovat de
deteriorri
organoleptice,
de
alterarea
produselor alimentare, este foarte variat,
aparinnd diverselor genuri bacteriene, precum
i unele drojdii i mucegaiuri.
Dintre aceste genuri mai frecvent incriminate n
alterarea alimentelor apar: genul Streptococcus,
Lactobacilus, Achromobacter, Pseudomonas,
Enterobacter, Flavobacterium, Micrococcus,
Bacillus, Clostridium, Acetobacter etc., care au
important rol n ordinea frecvenei implicrii n
modificrile organoleptice, sau mai muli fungi
din genurile: Penicillium, Cladosporium, Mucor,
Rhozopus, Torula, Oidium, Sacharomyces etc.
Tema [Link] alimentelor
Microflora patogen se determin prin riscul ca
alimentele s vehiculeze [Link] descoperiri
erau cunoscute cu mult naintea secolului nostru, iar
prezena bacteriilor duntoare a fost dovedit de
perioada marilor descoperiri din epoca Pasteur-Koch
i confirmat de numeroase anchete epidemiologice.
Alimentele , prin microorganismele patogene pe care
le pot vehicula sau prin metaboliii lor toxici, pot
constitui cauze de [Link] mbolnvirile
provocate de bacteriile patogene sau condiionat
patogene vehiculate n alimente snt relativ puine,
totui prin caracterul exploziv, neajunsurile i
rsunetul psihologic de care se nsoesc, constituie o
problem sanitar de prim rang.
Tema [Link] alimentelor
Pe lng posibilitatea ca alimentul s
vehiculeze microorganisme patogene de la
om la om ca Salmonella typhi i paratyphi,
Vibrio cholerae, virusul hepatitei epidemice
etc.
S-a demonstrat i existena unor boli comune
omului i animalelor, antropozoonozele ca
tuberculoza,
antraxul,
bruceloza,
salmonelozele, febra aftoas, leptospiroza,
tularemia etc., precum i riscul ca unele
alimente s conin larvele unor helmini, sau
s fie contaminate cu oule embrionare ale
altora ( nematode) sau cu protozoare.
Tema [Link] alimentelor
n acelai timp s-a observat c produsele alimentare infectate cu unele
bacterii patogene i pstrate n condiii favorabile pentru proliferarea
microorganismelor, pot genera toxiinfecii alimentare, unele chiar i prin
germeni cu patogenitate redus.
n etiologia toxiinfeciilor alimentare snt implicate anumite bacterii
patogene i condiionat patogene, care dup modul de aciune i
formele de manifestare ale maladiei , se grupeaz n:
Bacterii care provoac mbolnviri cu caracter infecios prin multiplicarea
n organismul uman a germenilor adui de alimente:Sallmonella,
Shigella, Escherichia coli, Vibrio parahaemolyticus.
Bacterii care acioneaz prin exotoxine elaborate n aliment nainte de a fi
ingerat: Staphylococcus, Streptococcus, Clostridium botulinum.
Bacterii ale cror mecanisme de participare n toxiinfecii alimentare nu
este pe deplin elucidat: Clostridium perfringens, Bacillus cereus,
Bacillus subtilis-mezentericus, Proteus, enterococi etc.
n acest caz mbolnvirea poate fi datorat elaborrii de toxine
microbiene sau mai ales datorit produilor toxici rezultai din degradarea
componenilor alimentari.
Revenind la riscul vehiculrii prin alimete al unor micvroorganisme
patogene transmise de la om, sau de la animal la om, vom detalia unele
aspecte:
n legtur cu vehicularea patogenilor prin lapte
Tema [Link] alimentelor
n legtur cu vehicularea patogenilor prin lapte
(Mycobacterium tuberculosis), laptele constitue cea mai
important cale de transmitere, produsele lactate reprezint
calea cea mai frecvent de transmitere a brucelozei, de
asemenea laptele poate vehicula salmonelle, stafilococi
enterotoxici de la animal sau de la om i ali patogeni. Dintre
microorganismele patogene transmise prin carne, pe prim
plan se situeaz salmonelele apoi mult mai rar bacilul
Koch, brucelele,
Bacillus anthracis, Clostridium
botulinum, leptospirele etc.
Carnea i preparatele din carne, petii , crabii, molotele etc.
pot fi contaminate cu formele infestate ale unor parazii:
Trichinella spiralis etc.
n urma cunoaterii treptate a surselor i a condiiilor care
favorizeaz apariia riscului de contaminare microbian i
parazitar a alimentelor, s-au precizat la vremea lor i
msurile adecvate de prevenire, msuri care au intratt n
practica i legislaia igienico-sanitar.
Tema [Link] alimentelor
[Link] ntlnite n alimente
[Link] microorganisme ca i celelalte bacterii din mediul
nconjurtor snt microorganisme unicelulare, solitare, mai rar coloniale,
uneori miceliene, cu oragnizare celular de tip procariot, din genul
Monera.
Au o deosebit plasticitate funcional i o intens activitate
[Link] de nutriie predominant este absorbia sau asimilarea,
ns multe grupe de bacterii snt chemosintetice, mult mai rar fotosintetice,
respectiv autotrofe sau [Link] saprofite, parazite sau
[Link] reproduc asexuat prin ciziparitate , ceea ce a dus n
determinatorul Bergeyan la poziionarea lor n clasa a II-a
[Link] ubicuitare.
Bacteriile mai frecvent ntlnite n produsele alimentare aparin la trei
ordine ( Pseudomonadales, Eubacteriales, Actinomycetales),
aproximativ 14 familii i la peste 50 genuri bacteriene. Fiecare gen
are funciile sale particulare de nutriie i procese degradative
consecutive. Cuprind relativ numeroase specii, varieti, tulpini i forme
capabile de dezvoltare i multiplicare n condiii ecologice, att de diferite
din alimente.
Tema [Link] alimentelor
Aciune pe substratul alimentar i patogenitatea snt coordonate cele mai
nsemnate ce definesc importana bacteriilor din alimente pentru economie i
pentru sntatea public.
Virusurile. Rolul precis pe care l joac alimentele n transmiterea virusurilor la
om este relativ puin studiat n [Link] i cultivarea virusurilor din
alimente este mult mai deficil i mai de durat dect pentru bacterii.
Problema se remarc concomitrnt cu dezvoltarea modern a tehnologiei
alimentare: utilizarea larg a refrigerrii i congelrii alimentelor pentru pstrarea
produselor alimentare perisabile netratate termic, risc s conserve virusurile
odat cu oprirea sau suprimarea dezvoltrii majoritii microorganismelor
patogene.
Caracterele principale ale virusurilor animalelor determin grupe de virusuri
animale, care pot fi transmise i prin alimente:
Enterovirusuri, poliovirusurile, virusul hepatitei epidemice etc.
Myxovirusuri, virusul gripal, virusurile parotiditei epidemice, rujeolei, virusurile
paragripale, virusul pestei porcine etc.
Adenovirusuri diferite a vieilor, porcinelor, psrilor, inxlusiv a omului.
Papovavirusuri-rol oncogen posibil
Alte grupe de virusuri.
Tema [Link] alimentelor
Contaminarea poate fi primar: de la animalele infectate prin esuturi,
secreii i materii fecale) sau secundar prin manipularea neigienic a
[Link] de intrare depinde de stabilitatea virusului i de tropismul lui
tisular.
n carnea provenit de la animalele infectate, rezistena virusurilor este variabil
n funcie de coborrea de pH n timpul regiditii musculare i de protecia oferit
de esuturile limfoide.
Alimentele servesc ca vehicul frecvent pentru cel puin dou boli virotice la om:
poliomielita i hepatita [Link] virotic care a fost cel mai mult studiat
n ceea ce privete transmiterea alimentar a fost hepatita infecioas.
Prin alimente se pot transmite i virusuri nepatogene sau rar patogene pentru
[Link] febrei aftoase, localizndu-se la gur, picioare i gland mamar
se rspndete mai uor sau foarte uor, asa c n caz de epizootie se
mbolnvesc aproape toate animalele.
Virusul pestei porcine infecteaz deseori oile, [Link] fi transmis prin carne
infectat.
Viabilitatea virusurilor n alimente depinde n primul rnd de factorul
[Link] ( refrigerarea, congelarea) inactiveaz mai puin virusurile,
uneori chiar le [Link] factori care influeneaz viabilitatea virusurilor snt:
compoziia chimic a alimentelor. pHul, agenii oxidani, radiaii, uscarea etc.
Tema [Link] alimentelor
Fungii: drojdiile i mucegaiurile.
Levurile
sau drojdiile reprezint un grup taxonomic heterogen de
microorganisme cu organizare eucariot, care se nmulesc prin nmugurire, prin
procese [Link] au form sferic, oval sau alungit, uneori
[Link] ca surs de carbon diferite zaharuri , acii organici,
glicerol, iar ca surs de azot produse rezultate din hidroliza proteinelor, pH optim
este de 4,5-5,0.n aerobioz levurile realizeaz fermentaia alcoolic a
zaharurilor cu producere de CO2 i alcool etilic.
Levurile sunt foarte larg rspndite n natur i sunt pe larg folosite n practic
pentru obinerea unor produse prin activitatea lopr fermentativ n industria
spirtului, vinificaiei, panificaiei, industria berii, pentru producia de mas celular
n calitate de drojdii furajere, drojdie de bere i pentru extragerea din culturile lor
a unor vitamine din grupul B, B1,B2 i a provitaminei D.
Drojdiile mai frecvent ntlnite n i pe alimente aparin genurilor:
Saccharomyces, Torulopsis, Rhodotorula, Candida etc.
Drojdiile nu sunt patogene, dac sunt absorbite pe cale [Link] genurile
citate unele sunt chiar foarte utile n industria alimentar, iar altele sunt
rspunztoare de alterarea unor importante produse alimentare.
Tema [Link] alimentelor
Mucegaiurile. Reprezint fungi filamentoi care se
reproduc prin spori asexuai i [Link] plante fr
clorofil cu structur celular de tip eucariot, rspndite
pretutindeni n natur: ap, sol, aer, plante, [Link]
mai important este riscul de mbolnvire asupra
consumatorilor.S-a
demonstrat
apariia
diverselor
micotoxine n produsele alimentare, numeroase cercetri
au pus n eviden efectele nocive ale lor: cancerigene,
hepatotoxice, nefrotoxice, anemiante, toxice nervoase. Au
fost decoperite unele [Link] cunosc aflatoxine
produse de mucegaiuri cum ar fi Aspergillus flavus,
Penicillium, Rhizopus.
Aciune cancerigen au micotoxinele: sterigmatocistina,
patulina, luteoschirina etc.
Mucegaiurile din genul Fusarium secret diverse
micotoxine: fusariogenina, poina etc.
Tema 9. Interrelaii ecologice aliment-microorganism
[Link] produselor alimentare.
Fiecare aliment este caracterizat printr-un grup de parametri intrinseci
constituit din: apa disponibil; pH; potenial de oxidoreducere, compoziie
n factori nutritivi; substane antimicrobiene; o structur biologic care
este n stare s prentmpine intrarea multor microorganisme.
Un factor deosebit de important al mediului intrinsec din aliment este
faza apoas i ndeosebi apa activ, nelegat, disponibil, care
condiioneaz de fapt dezvoltarea, multiplicarea microorganismelor i
activitatea enzimatic n alimente. Alimentele bogate n ap ( 70-90%)
snt perisabile, de scurt durat, spre deosebire de alimentele desicate,
uscate care au o durabilitate lung.
Ph-ul i capacitatea de tampon a substratului au efect selectiv asupra
microflorei din alimente .Alimentele ca laptele i carnea, prin compoziia
n factori nutritivi ( proteine, lipide, vitamine etc.), prin apa disponibil i
prin pH-ul convenabil constituie medii foarte bune pentru multiplicarea
diverselor microorganisme
Tema 9. Interrelaii ecologice aliment-microorganism
Dup compoziia n factori nutritivi a alimentelor se selecteaz o anumit
flor microbian, n funcie de substratul asupra creia acioneaz
predominant- flora proteolitic, lipolitic, [Link] cu o
concentraie crescut de zahr i de sare nu constituie un mediu prea
prielnic pentru dezvoltarea [Link] ns microorganisme
care suport aceste presiuni osmotice mari- microorganismele
osmobiotice.
n alimente se selecteaz o anumit flor microbian n funcie de
substratul asupra creia acioneaz [Link], laptele i
derivatele de lapte, alimente cu un coninut mare de ap i mai ales n
factori nutrutuvi, constituie medii prielnice dezvoltrii microorganismelor
nedorite.n condiii obinuite, aceste microorganisme pot fi inhibate de
concurena bacterian i de mediul acid pe care l creaz flora de
fermentaie lactic spontan sau adugat [Link] ns frecvente
situaii, cnd paralel cu aceast flor se dezvolt microorganisme
nedorite, n special microorganisme cu activitate proteolitic, vinovate de
alterarea laptelui
i produselor lactate, ca: bacilii nesporulai
( colibacilii, Pseudomonas, Achromobacter, Proteus etc.), coci
( Streptococcus faecalis), bacili aerobi sporulai ( genul Bacillus),
sau anerobi sporulai din genul Clostridium etc.
Tema 9. Interrelaii ecologice aliment-microorganism
Dintre factorii extrinseci care influeneaz microflora din alimente prezint
importan n special: temperatura de stocare, umiditatea relativ a mediului de
depozitare, prezena sau absena gazelor ca:CO2 i O3, radiaiile etc.
n funcie de nivelul termic microorganismele se mpart n trei categorii:
Psihrofile, care i desfoar procesele vitale la frig.
Mezofile, care i desfoar procesele vitale la temperaturi medii.
Termofile, care i desfoar procesele vitale la temperaturi ridicate.
Cea mai joas temperatur la care s-a semnalat multiplicarea bacteriilor este
aproximativ -20C. i cea mai nalt puin peste 90C.
Prin alterarea ( din latinexul alter-altul) unui aliment ar trebui de neles orice
modificare a strii lui normale inclusiv defectele. ntruct prin analizatorii si, omul
sesiseaz numai modificrile nsuirilor organoleptice, practic alterarea cuprinde
numai o schimbare defavorabil a acestor nsuiri, care tulbur aspectul psihoafectiv al relaiei dintre om i aliment. Adeseori alterarea este nsoit sau curnd
urmat de nocivizare i de reducerea sau chiar de anularea valorii nutritive a
produsului respectiv, adic ea este un proces complex interesnd i celelalte
aspecte ale relaiei om-aliment de care depinde calitatea unui produs alimentar.
Tema 9. Interrelaii ecologice aliment-microorganism
Prin alterare nelegem modificarea proprietilor
organoleptice ale unui aliment sub aciunea enzimelor proprii
i n special prin proliferarea i activitatea enzimatic a
microorganismelor ce se pot dezvolta pe i n aliment.
Cauzele alterrii sunt determinate de :
Modificri fizice care includ deformri mecanice, prezena
de impuriti, pierderea de ap sau dimpotriv acceptarea de
ap,
cristalizarea
unor
soluii
aproape
saturate,
contaminarea cu substane odorante care modific
prprietaile organoleptice etc.
Modificri biochimice ( biologice) care includ dereglri prin
ativitatea anzimelor proprii; dezvoltarea elementelor de
reproducere a speciei ( embrionarea oului, ncolirea unor
legume etc.); prin proliferarea i activitatea enzimatic a
microorganismelor care se dezvolt pe li un aliment.
Tema 9. Interrelaii ecologice aliment-microorganism
Natura microorganismelor depinde n primul rnd de compoziia produsului
alimentar, de substratul asupra cruia acioneaz i de condiiile n care
acioneaz agentul: coninutul n ap i presiunea osmotic a alimentului,
aciditatea ( pH-ul), temperatura ambiant etc.
Microorganismele acioneaz datorit urmtoarelor
mecanisme de
aciune:
Proteoliz-peptone, aminoacizi din care prin desmoliz se formeaz amine,
oxiacizi, amoniac, hidrogen sulfurat, indol, scatol [Link] dau produselor un
miros foarte neplcut de putrefacie, iar multe dintre ele au i efecte toxice sau
iritante pentru mucoasa tubului digestiv.
Fermentaia glucidelor i a derivailor lor ( alcoolic, lactic, acetic, propionic,
butiric etc.) i rezultatele sale nedorite, defavorabile.
Lipoliza sau rncezirea grsimilor prin hidroliz i oxidare. Hidroliza enzimatic
este produs de lipaze proprii tisulare i n special de lipaze elaborate de bacterii
lipolitice i de mucegaiuri, oxidarea este favorizat de oxidaze tisulare i
microbiene, cu formare de peroxizi, aldehide, cetone etc.
Formarea de pigmeni care modific culoarea normal a produselor alimentare,
prin aciunea microorganismelor cromogene.
Tema 9. Interrelaii ecologice aliment-microorganism
n timpul alterrii, prin activitatea enzimatic a
microorganismelor i descompunerea substratului aliment
apar modificri organoleptice: schimbarea aspectului
general, apariia unor mirosuri dezaagreabile sau
respingtoare, modificarea gustuluii sau generarea unei
senzaii neobinuite.
Concomitent poate avea loc formarea de substane
duntoare sntii: tiramina,triptamina, histamina etc.
Dei majoritatea bacteriilor care provoac alterarea
produselor alimentare sunt nepatogene sau numai
condiionat patogene, totui cnd proliferarea lor este intens
i produii rezultai din metabolismul propriu acioneaz
concomitent cu cei provenii din descompunerea alimentelor,
efectul se poteneaz reciproc i ele devin nocive, genernd
toxiinfecii prin consum de alimente alterate.
Tema 9. Interrelaii ecologice aliment-microorganism
[Link] dominant n alterarea unor produse alimentare
Carnea este cea mai perisabil dintre alimentele mai [Link]
conine o abunden din toate principiile nutritive necesare pentru
creterea bacteriilor, drojdiilor i mucegaiurilor.
Microflora crnii relativ proaspete, a petelui proaspt poate fi
determinat de variate genuri de bacterii saprofite: Aeromonas,
Aerobacter, Alcaligenes, Escherichia, Flavobacterium, Lactobacillus,
Leuconostoc, Micrococcus, Vibrio etc.
Diverse genuri de mucegaiuri au fost izolate din carnea i petele
relativ proaspt:Penicillium, Cladosporium, Mucor, Aspergillus,
Alternaria etc. i s-au determinat urmtoarele genuri de drojdii:
Candida, Sacharomyces, Torulopsis, Torula etc.
Cele mai multe studii privind alterarea crnii s-au fcut pe carnea de
[Link] carnea de porc, oaie etc. se presupune c se altereaz
ntr-un mod asemntor. Dup depozitarea prelungit la temperatura
0-+5C ncepe alterarea microbian.n carnea alterat la temperatura
frigiderului, investigaiile microbiologice relev urmtoarele aproximativ
opt genuri de bacterii: Pseudomonas, Achromobacter, Proteus,
Micrococcus,
Flavobacterium,
Aeromonas,
Streptococcus,
[Link] dou genuri se gsesc mai frecvvent.
Tema 9. Interrelaii ecologice aliment-microorganism
Temperatura de incubare este principala
cauz pentru care doar un numr mai restrns
de genuri de bacterii se gsesc n carnea
alterat spre deosebire de carnea proaspt.
Feliile de carne tind s sufere o alterare de
suprafa, microorganismele alterrii fiind
bacteriile sau [Link] de carne de
la frigider, cu umiditate crescut, sufer
preferenial alterare [Link]
esenial a acestei alterri este mzga la
suprafaa
n
care
se
gsesc
microorganismele incriminate.
Tema 9. Interrelaii ecologice aliment-microorganism
[Link] patogen n alterarea unor produse alimentare.
Laptele este un excelent mediu de cultur i de protejare pentru multe
[Link] [Link], [Link], Brucella, toate
virusurile nu se nmulesc n lapte.
Ali germeni patogeni [Link], [Link], [Link] se pot multiplica
n lapte.
Agenii microbieni din lapte provin de la animalul productor de lapte,
de la om sau din [Link] pot fi excretai direct din uger n lapte sau
pot proveni de pe pielea i mucoasele animalului i mulgtorului.
Apele poluate, insectele, roztoarele pot fi de asemenea surse de
contaminare a [Link] poate fi o surs de contaminare a laptelui
n orice verig a procesului de producie.
Staphylococcus aureus este frecvent purtat de oamenii aparent
sntoi, care manipuleaz laptele i produsele lactate, precum i de
animalele n [Link] i pielea animalelor n lactaie constituie o
surs important de poluare a laptelui
Mamita stafilococic este destul de frecvent de [Link],
[Link], [Link].
Animalele n lactaie pot contacta infecii localizate sau generalizate
provocate de streptococii din diferite grupe serologice, care sunt
patogeni pentru om
Tema 9. Interrelaii ecologice aliment-microorganism
streptococii hemolitici din grupa A ( [Link]), streptococii din grupa
B, Diplococcus pneumoniae.
Laptele frecvent se infecteaz cu specia Salmonella, care reprezint
agentul febrei tifoide i [Link], untul i brnzeturile au fost
responsabile de unele epidemii de febr tifoid. Salmonelele ajung n
lapte n special dup [Link] termosensibile, ele sunt distruse n
timpul pasteurizrii.
Laptele reprezint o surs de contaminare cu Brucella. Infecia
bruceloza reprezint o zooantroponoz [Link] etiologic brucella
este bine vehiculat de lapte prin care se pot contamina oamenii.n
prezent se consider c majoritatea oamenilor, care se mbolnvesc de
bruceloz se infecteaz prin contactul direct cu esuturile i secreiile
animalelor infectate sau prin inhalarea prafului poluat cu Brucella.
Omul se poate infecta cu speciile : [Link], [Link],
[Link]
mai
periculoas
specie
pentru
om
reprezint:[Link].
Tema 9. Interrelaii ecologice aliment-microorganism
Brucella din laptele crud contaminat i netratat termic trece
n produsele [Link] este obinuit mai puternic
contaminat dect restul laptelui i conserv germenii vii mai
mult timp.
Laptele bolnave de tuberculoz n timpul lactaiei reprezint
principala surs de infecie cu Mycobacterium [Link]
tuberculozei ptrunde n lapte prin intermediul laptelui
infectat, diverse leziuni.
Bacilul tuberculozei din lapte este omort ntottdeauna prin
tratamente [Link] poate fi contaminat cu
[Link] prin intermediul mulgtorilor sau al altor
manipulatori.
Bacillus anthracis se ntlnete mai rar n lapte sau prin
consumul de [Link] provenit de la animalele bolnave
sau suspecte la antrax s se exclud din alimentaie.
Tema 9. Interrelaii ecologice aliment-microorganism
Frecvent n lapte se ntlnete Clostridium [Link] bacteriei
persist foarte mult timp n sol, praf etc. Aproximativ 16-18% din laptele
pasteurizat este contaminat cu [Link], care provoac diverse
gastroenterite.
Laptele frecvent este infectat cu speciile Clostridium botulinum,
Clostridium diphteriae, Listeria monocytogenes, Leptospira etc. O
problem deosebit pentru sntatea omului o pot constitui levurile i
mucegaiurile toxigene, care contamineaz i se pot multiplica n unele
brnzeturi, producnd aflotoxine.
Carnea poate avea o flor microbian foarte variat, n funcie de
posibilitile de infectare a ei, att n timpul vieii animalelor, ct i dup
sacrificare.
Temperatura nalt, umiditatea mare, permit
bacteriilor s se
nmuleasc permind nmulirea bacteriilor att la suprafa ct i n
profunzimea crnii, cunoscute sub denumirea de alterare sau procesul
de putrefacie al crnii
Tema 9. Interrelaii ecologice aliment-microorganism
Se ntlnesc bacteriile anaerobe facultativ i aerobe cum sunt: micrococii,
bacilii din grupul Pseudomonas, Proteus, Achromobacter, [Link],
[Link] , bacteriile anaerobe [Link], [Link],
[Link] etc.
Putrefacia se poate produce i la temperaturi joase, unde intervin pe
lng bacteriile criofile i mucegaiurile din genurile Mucor, Penicillium,
Aspergillus.
Carnea se poate infecta cu bacteriile patogene: Salmonella, Bacillus,
Mycobacterium.
Prin intermediul carnii la om se transmit infeciile rujetul, bruceloza,
tularemia, morva.
Poluarea oulor cu bacterii se face atunci cnd cuibarele sunt murdare
sau manipularea se face n condiii necorespunztoare sau sunt
depuse pe sol contaminat
Tema 9. Interrelaii ecologice aliment-microorganism
De pe coaja oulor se izoleaz mai frecvent
bacterii din genurile Proteus, Pseudomonas care
au rol de alterare a oulor
Salmonella a fost izolat de pe coaja oulor ct i
din interiorul oulor, fiin responsabil de
toxiinfeciile alimentare la om
n ou se izoleaz specile bacteriene Salmonella
enteritidis, [Link], [Link], Mycobacterium avium.
n albuul proaspt bacterii sunt, fie absente, fie n
numr foarte redus, datorit aciunii bactericide a
lizozimului
Tema 10. Microflora laptelui
1. Principalele microorganisme ale laptelui normal.
Microorganismele din lapte i din produsele lactate sunt constituite din:
bacterii, drojdii i mucegaiuri. Bacteriile sunt cele mai numeroase i pot
avea form sferic (coci) sau de bastonae (bacili). Corpul lor este
format dintr-o singur celul, dar se pot grupa sub diferite forme (lanuri,
ciorchine, cte dou). n general, bacteriile ca i majoritatea
microorganismelor se nmulesc ntre 30 i 40 C.
Unele specii prefer temperaturi mai sczute pn la 10 C (psihrofile)
sau temperaturi mai ridicate, de 40-50 C (termofile). Temperaturile
peste 60 C distrug bacteriile, n marea lor majoritate, rezistnd numai
cele care se nmulesc prin spori. Scderea temperaturii, chiar sub 0 C,
nu distruge microorganismele, ci oprete numai dezvoltarea acestora.
Drojdiile se gsesc n numr mai mic n lapte, dezvoltndu-se pe medii
acide i producnd alcool i dioxid de carbon. n diverse produse ele pot
da un gust nedorit.
Tema 10. Microflora laptelui
Microflora
Normal
(prielnic)
Anormal(dunt
oare)
Patogen
Bacterii lactice
Bacterii butirice
M. tuberculosis
Bacterii
propionice
Bacterii
putrefacie
Brucella
Drojdii tipice, etc
Grupa E. coli
aerogenes
Bacteriofagi
de
Salmonella
Tema 10. Microflora laptelui
Mucegaiurile apar ntmpltor n lapte. Aceste microorganisme joac un
rol nedorit n tehnologia laptelui. Cel mai frecvent dintre mucegaiuri, n
lapte se ntlnete Oidium lactis, denumit i mucegaiul laptelui. El se
dezvolt la suprafaa produselor lactate acide i a brnzeturilor, formnd o
pelicul catifelat alb-glbuie. Petele de mucegai verde sau neagr de
pe suprafaa untului i a brnzeturilor pstrate necorespunztor pot fi
formate de Penicillium glaucum, Aspergillus niger sau Mucor .
Microorganismele acioneaz asupra lactozei, proteinelor i lipidelor din
lapte. Cea mai important microflor a laptelui este determinat de
bacteriile lactice nesporulente, gram pozitive.
Dup modul de fermentare a lactozei, bacteriile lactice pot fi
homofermentative i heterofermentative.
Bacteriile homofermentative transform lactoza n acid lactic. Bacteriile
heterofermentative transform lactoza n acid lactic (formarea este cu
mult mai lent) i ali produi imprimnd unor produse lactate gust i
arom specific.
Tema 10. Microflora laptelui
Aceste bacterii sunt pretenioase fa de mediul vital, necesitnd
prezena n el, n afar de lactoz, a acidului citric, a vitaminelor i
aminoacizilor.
Bacteiile lactice sunt prezentate de genul Streptococcus i genul
Lactobacillus.
Genul Streptococcus este reprezentat de S. lactis, S. termophilus, S.
cremoris, S. citrovorum etc. Sunt germeni dominani n lapte, smntn i
brnzeturi. Practic nu exist lapte crud fr streptococi. Ei produc o
aciditate moderat.
Genul Lactobacillus are un rol mai redus n industria laptelui n
comparaie cu streptococii. Se dezvolt la 35-37 C i au o putere de
acidificare mai mare, formnd pn la 37% acid lactic.
n industria laptelui au un rol important speciile: L. bulgaricus,
[Link], L. casei. L. bulgaricus se folosete n componena
culturilor starter pentru prepararea iaurtului, laptelui acru etc.
Concomitent cu S. thermophillus fac parte din componena maielelor la
prepararea chefirului,
Tema 10. Microflora laptelui
cumsului. Lactobacillus acidophillus este componentul principal al
culturilor starter pentru prepararea laptelui acidofil, a pastei acidofile etc.
Aceste produse au caliti curative pronunate i se folosesc pe larg la
tratarea diferitor boli gastrointestinale.
Bacteriile propionice sunt prezente n laptele proaspt, dar se dezvolt n
brnzeturi cu perioada lung de maturare. Aceste bacterii transform
acidul lactic, n acid propionic, acid acetic i dioxid de carbon, ct i n
alte produse (alcool etilic, acid formic) n substane ce imprim gustul i
aroma produselor lactate respective.
Bacteriile propionice sunt cuprinse n dou genuri: Eubacterium i
Propionibacterium. Principala specie din genul Propionibacterium cu
semnificaie pentru tehnologia produselor lactate este P. freudenreichi
gsit de Orla-Jensen i Freudenreich n anul 1906 n brnza Schweizer,
la care determin formarea ochiurilor caracteristice de fermentaie .
Tema 10. Microflora laptelui
Microflora anormal sau duntoare din lapte este prezentat de
bacteriile butirice, de putrefacie, bacteriile coli-aerogenes, bacteriofagi
etc. Bacteriile butirice ajung n lapte din mediul nconjurtor, n special
din silozul necalitativ. Fermenteaz lactoza i acidul lactic n acid butiric,
dioxid de carbon i hidrogen. Produsele formate imprim produselor
lactate un gust amar i miros neplcut, aduc mari daune produciei de
brnzeturi, provocnd balonarea trzie a acestora.
Bacteriile de putrefacie ajung n laptele crud, n special din vasele
curate necalitativ. Aceste bacterii au aciune proteolitic, provocnd
descompunerea proteinelor din lapte pn la amoniac i dioxid de
carbon, substane ce imprim produselor lactate miros i gust neplcut.
Totodat n tehnologia laptelui un rol nedorit joac mucegaiurile. Cel mai
frecvent dintre mucegaiuri, n lapte se ntlnete Oidium lactis, denumit
mucegaiul laptelui.
Petele de mucegai de culoare verde sau neagr de pe suprafaa
untului i a brnzeturilor pstrate necorespunztor pot fi formate de
Penicillium glaucum, Aspergillus niger Mucor mucedo
Tema 10. Microflora laptelui
Structura i compoziia chimic complex a laptelui
constituie un mediu nutritiv, foarte favorabil dezvoltrii
microorganismelor. Microorganismele din lapte provin din
mediul extern dar i din cel intern. Din mediul extern, un
mare numr de microorganism ptrund n lapte din uger pe
canalele sfrcurilor mamare.
mbogirea laptelui n microorganisme se face n timpul
mulsului, n raport cu starea de igien din aer, de pe uger, de
pe minile mulgtorilor, de pe vase, utilaje, tifoanele de
filtarare , n timpul condiionrii i conservrii primare.
Din mediul intern, microorganismele pot aprea n lapte n
cazul mamitelor i filtrrii prin epiteliul glandular al mamelei a
unor microorganisme pe care animale le vehiculeaz n
organism n anumite boli sau stri fiziologice speciale .
Tema 10. Microflora laptelui
Laptele provenit de la animale sntoase i muls n
condiii de asepsie conine cteva sute de germeni pe ml.
Un lapte recoltat n condiii de igien necorespunztoare va
conine un numr mare de microorganism pe ml, acest
numr ajungnd pn la cteva milioane.
n condiii normale, n lapte vacilor sntoase se ntlnesc
microorganism care se pot clasifica n trei grupe:
Grupa bacteriilor lactice. Acestea snt echipate cu
enzime glicolitice homo- sau hetrofermentative i
peptonizate. Unele din ele snt microorganisme care se
ntrebuineaz industrial la producerea maielelor folosite n
industria laptelui, avnd deci rol utilitar.
innd cont de clasificarea microorganismelor, dup
Bergey, bacteriele lactice aparin familiei
Lactobacteriaceae .
Tema 10. Microflora laptelui
Familia Lactobacteriaceae cuprinde subfamiliile: Streptococcaceae i
Lactobacillaceae. Din subfamilia Streptococcaceae mai inportante snt
genurile Streptococcus i Leuconostoc. Principalele specii de
Streptococcus snt:
- Str. lactis i Str. cremoris care snt agenii obinuii ai acidifierii
spontane a laptelui;
- Str. thermophylus component principal al microflorei iaurtului,
agentul acidifierii laptelui i coagulrii brnzei veier i Gruiere;
- Str. bovis, care este foarte des ntlnit n lapte i intestinele bovinelor;
- Str. fecalis, ntlnit n materiile fecale i lapte, producnd gustul amar
la brnzeturile preparate din laptele ce-l conin;
Str. lequefaciens, present n materiile fecale i lapte i care produce
acelai gust amar brnzeturilor ca i precedentul.
Din genul Leuconostoc fac parte dou specii mai importante: L.
citrovorum i L. paracitrovorum. Ambele microorganisme formeaz
diacetil n smntn. Ele snt microorganismele aromatizante ale
smntnii fermentate i ale untului.
Tema 10. Microflora laptelui
Din subfamilia lactobacillaceae au importan mai mare dou genuri:
Lactobacillus i Propionibacterium. Genul Lactobacillus cuprinde
trei
subgenuri:
Thermobacterium,
Streptobacterium
i
Betabacterium.
Subgenul Thermobacterium este termofil, dezvoltndu-se la temperature
de 37C - 60C. n el se ncadreaz:
Thermobacterium lactis (Lactobacillus lactis) i Thermobacterium
helviticus (Lactobacillus helviticus), care produc acidifierea brnzei
vaier i Gruiere;
Termobacterium bulgaricum (Lactobacillus bulgaricum) care este
unul din componenii principali ai microflorei iaurtului;
Thermobacterium acidophylum (Lactobacillus acidophilus) care
este bacteria principal a laptelui acidofil.
Subgenul Streptobacterium cuprinde microorganisme care se dezvolt
bine la temperaturi de 28 32C. n acest subgen se menioneaz ca
specie mai inportant Streptobacterium casei (Lactobacillus casei,
Bacterium casei) care are rol important n maturarea brnzeturilor, fiind o
bacterie puternic proteolitic [33,40].
Tema 10. Microflora laptelui
roii pe suprafaa brnzeturilor.
Grupa bacteriilor de poluare. n aceast grup intr bacterii
saprofite, care pot provoca deprecierea laptelui i produselor
lactate. n general, aceste microorganisme desfoar pe
baza echipamentului enzimatic o aciune proteolitic. Aceast
grup cuprinde germenii din mai multe familii i anume:
- Familia Enterobacteriaceae are ca reprezentani genul
Escherichia, Enterobacter i Proteus. Din genul Escherichia
fac parte Escherichia coli, iar din genul Enterobater- E.
aerogenes i [Link]. Din ultimul gen fac parte P. vulgaris, P.
mirabilis, P. morganii. Pentru lapte i produse lactate,
cercetarea E. coli servete ca un indicator igienico sanitar
la aprecierea gradului de poluare. E. coli n asociere cu E.
aerogenes produc balonarea precoce a brnzeturilor;
Tema 10. Microflora laptelui
- Familia Bacillaceae este reprezentat de
genul Bacillus i Clostridium. Genului
Bacillus i aparin microorganisme ce se
gsesc pe furaje, de unde trec n lapte i n
sol i sunt reprezentai de: B. mycoides, B.
subtilis, B. mezentericus, B. cereus. Din
genul Clostridium intereseaz Cl. butyricum,
cu varietatea Cl. tirobutyricum ce produce
balonarea brnzeturilor i Cl. sporogenes,
care produce putrezirea alb a brnzeturilor,
Mycobacterium tuberculosis, S. aureus;
Tema 10. Microflora laptelui
- Familia Pseudomonaceae poate fi reprezentat n lapte de P.
fluorescenes, care produce rncezirea untului i P. aeruginosa care are
aciune proteolitic;
- Familia Rhisobacteriaceae are ca reprezentant Alcaligenes faecalis,
care este foarte frecvent izolat din lapte i d gustul de nbuit;
- Familia Nitrobacteriaceae cuprinde genuri care provoac laptelui i
brnzeturilor unele modificri ale caracterelor organoleptice.
Mai inportante sunt genurile: Nitrobacter, Nitrosomonas i
Nitrosococcus;
- Familia Micrococcaceae este reprezentat de M. freudenreichi i M.
caseolyticus. Prima d aspect filant smntnii, iar secunda are aciune
de descompunere a cazeinei .
Grupa drojdiilor i mucegaiurilor. Laptele poate conine levuri i
mucegaiuri. Genurile cele mai frecvent ntlnite sunt:
- Saccharomyces care are ca reprezentant pe S. fragilis. Acest gen
fermenteaz lactoza i uneori poate produce balonarea brnzeturilor
slabe. n chefir i kums s-au pus n eviden S. chefiri ( S. lactis);
- Torulopsis care are un numr mare de specii. Fermenteaz lactoza i
produce modificri ale laptelui concentrat cnd siropul nu a fost
sterilizat;
Tema 10. Microflora laptelui
- Familia Pseudomonaceae poate fi reprezentat n lapte de P.
fluorescenes, care produce rncezirea untului i P. aeruginosa care are
aciune proteolitic;
- Familia Rhisobacteriaceae are ca reprezentant Alcaligenes faecalis,
care este foarte frecvent izolat din lapte i d gustul de nbuit;
- Familia Nitrobacteriaceae cuprinde genuri care provoac laptelui i
brnzeturilor unele modificri ale caracterelor organoleptice. Mai
inportante sunt genurile: Nitrobacter, Nitrosomonas i Nitrosococcus;
- Familia Micrococcaceae este reprezentat de M. freudenreichi i M.
caseolyticus. Prima d aspect filant smntnii, iar secunda are aciune
de descompunere a cazeinei .
Grupa drojdiilor i mucegaiurilor. Laptele poate conine levuri i
mucegaiuri. Genurile cele mai frecvent ntlnite sunt:
- Saccharomyces care are ca reprezentant pe S. fragilis. Acest gen
fermenteaz lactoza i uneori poate produce balonarea brnzeturilor
slabe. n chefir i kums s-au pus n eviden S. chefiri ( S. lactis);
- Torulopsis care are un numr mare de specii. Fermenteaz lactoza i
produce modificri ale laptelui concentrat cnd siropul nu a fost
sterilizat;
Tema 10. Microflora laptelui
Rhodotorula care produce pigment rou sau galben. Coloniile sunt roii
sau galbene. Se dezvolt pe brnzeturi, saramura folosit la brnzeturi i
uneori pe unt;
- Candida, care are ca reprezentant speciaa C. Krusei. Se dezvolt n
simbioz cu bacteriile lactice, crendu-le condiii de anaerobioz;
- Torula, care este reprezentant de T. dematia coloreaz brnzeturile n
negru;
- Oospora cu specia Oidim lactis, joac rol n maturarea unor brnzeturi;
- Penicillium cu speciile: P camemberti, P. roquefortii, P. casei, P.
caseolyticum, P. glaucum. Primele specii se folosesc la maturarea unor
brnzeturi (camemmbert, roquefort, gorgonzola, neufchateler etc.);
Scopulariopsis cu specia S. brevicaulis se ntlnete mpreun cu micei
din genul Penicillium;
Mucor cu speciile M. muceda i M. racemosus au fost izolai din lptarii,
de unde pot ajunge n lapte. Au fost identificai n untul rnced i laptele
praf;
Tema 10. Microflora laptelui
Rhizopus cu specia R. nigricans elaboreaz
enzime proteolitice i a fost izolat din
brnzeturile moi i unele sortimente de unt;
Cladosporium cu C. herbarum ajunge n lapte
prin murdrii.
Cladosporium butyri este ntlnit n unt. Pe
baza enzirmelor lipolitice elaborate, concur
la rncezirea untului .
Tema 10. Microflora laptelui
2. Sursele de contaminare a laptelui cu microorganisme
Varietatea microorganismelor din lapte i au originea prioritar extramarnar. Contaminarea
intravital a laptelui se produce prin ptrunderea microorganismelor din mediul extern
prin canalele- galactofore a animalelor sntoase. Primele jeturi de lapte muls au. o
ncrctur bacterian foarte mare, n comparaie cu laptele obinut la mijlocul sau sfritul
mulsului.
De asemenea, o contaminare-intravital a laptelui se produce i n cazurile cnd forele
de aprare ale organismului snt diminuate n anumite stri fiziologice speciale i stri
patologice generale sau locale ale ugerului (oboseal, surmenaj, subnutriie, carene
alimentare, boli generale, mastitele-etc.). Contaminarea extramamar are ponderea cea
mai mare i se realizeaz prin lipsa de igien elementar la muls, manipulare, transport.
Industrializare.
Factorii care influeneaz gradul de contaminare microbiologic a laptelui snt reprezentai
n primul rnd de actul mulsului mamelei, igiena mulgtorului, igiena vaselor de muls,
sistemul de muls, igiena adposturilor .
n timpul filtrrii laptelui la mulsul manual i mecanic o contaminare a acestuia se poate
produce prin lipsa de igien a tifoanelor de filtrare si printr-o manipulare
necorespunztoare. Starea de igien a vaselor i a aparatelor de muls au i ele un rol
important n contaminarea laptelui cu microorganisme Condiionarea laptelui prin rcire
este de asemenea un factor care influeneaz ncrctura microbian a laptelui. n acelai
context, se nscrie igiena lptriei, igiena transportului i a industrializrii.
Tema 10. Microflora laptelui
Pentru a obine lapte cu o ncrctur microbian ct mai redus, se impun
corective simultane ale tuturor factorilor de igien artai n complexitatea lor.
Un rol determinant l au corectivele aduse utilajelor de muls, mamare i
mulgtorilor.
Msurile ce se impun pentru reducerea contaminrii laptelui cu
microorganisme snt:
1. Cu 30 minute nainte de muls l n timpul mulsului se interzice furajarea
animalelor cu fibroase care produc praf i s se fac curirea adpostului i
primenirea aternutului;
2. Animalele se supun curirii corporale, li se leag coada de picior i li se
spal ugerul cu ap cald i spun, care apoi se terge cu un prosop curat;
3. Mulgtorul i va spla minile cu ap cald i spun i va purta
echipament de protecie i "sanitar (salopet, cisme, halat, bonet);
4. Vasele de muls, utilajele i instalaiile vor fi splate cu ap fierbinte cu
detergeni, dezinfectate cu o soluie de 2% de sod calcinat i apoi cltite
cu ap potabil;
5. Recoltarea primelor jeturi de lapte se face n vase separate. Acest lapte nu
se admite n consum public;
Tema 10. Microflora laptelui
6. Scoaterea laptelui imediat dup obinere din grajd i ducerea lui la lptrie
sau n camera de lapte. Bidoanele cu lapte nu se vor acoperi imediat cu
capacele, ci se vor acoperi cu tifoane curate;
7. Strecurarea se va face prin site metalice perfect curate i prevzute cu cel
puin 4 straturi de tifon perfect curat;
8. Rcirea laptelui imediat dup filtrare, dup introducerea bidoanelor n bazine
de ap curent. Apa din bazine trebuie s fie curgtoare si va ajunge pn la
nivelul laptelui din bidon, Capacele bidoanelor vor fi puse parial pe gura
acestora. La livrare, laptele va trebui s aib maximum + 14C. Rcirea corect
si intensiv se realizeaz n instalaii frigorifice speciale cu care snt dotate
unele uniti;
9. Mulgerea separat a animalelor bolnave de diverse boli generale, dar n mod
special a celor cu mamit, i interzicerea amestecrii acestui lapte cu laptele
normal:
10. Transportul i manipularea laptelui s se fac n condiii igienice i numai cu
mijloace autorizate, n corespundere cu normele sanitar-veterinare;
11. Spaiile n care se obine, colecteaz, prelucreaz sau se debiteaz lapte i
produse lactate, trebuie s corespund normelor sanitar-veterinare i vor fi
ntreinute igienic permanent, privind starea de curat fizic, curat chimic i curat
microbiologic;
12. Personalul mulgtor, manipulator i de prelucrare trebuie s fie sntos, s
nu alb plgi supurate pe mini, abcese, furuncule, s nu fie purttori de
Salmonella spp, sau ali germeni infecioi, periculoi pentru om, s se supun
periodic examenelor sanitare obligatorii i s respecte normele de igien
personal i general.
Tema 10. Microflora laptelui
Microflora lactic, de poluare i cea a laptelui produc o serie de transformri n lapte,
concretizate n procese fermentative asupra lactozei i proteinelor. Unele din aceste
procese snt utilizate pe scar industrial. Altele snt duntoare, nedorite, producnd depre
cieri ale laptelui.
Sub raport biologic, n lapte se succed patru faze l anume:
[Link] bacteriostatic. Aceast faz a fost semnalat de Foker n 1980, n cazul mulgerii
igienice a laptelui, numrul iniial de microorganisme nu se multiplic i se poate observa
chiar o reducere a numrului lor pe ml Aceast scdere sau oprire a multiplicrii
microorganismelor se menine n jur de 36 ore i este determinat de:
-perioada de adaptare a microorganismelor, de acomodare la condiiile oferite de lapte;
-prezena n lapte de substane cu efect inhibitor asupra microorganismelor. Aceste
substane snt reprezentate de lactenina l, 2, 3, aglutinine i penicilinaz etc.
Durata fazei bacteriostatice este condiionat de ncrctura iniial cu microorganisme a
laptelui, de cantitatea de substane inhibitoare din lapte i de temperatura de pstrare a
laptelui.
Prelungirea fazei bacteriostatice a laptelui are o semnificaie practica deosebit. Rezult
c se impune o mulgere igienic i o rcire intensiv i imediat a laptelui pentru a mri
durata fazei bacteriostatice a laptelui proaspt.
Tema 10. Microflora laptelui
Cercetrile recente au evideniat faptul c un lapte rcit la +4C pn la +5C n instalaii
frigorifice la ferme asigur premisa livrrii lui dup 48 sau 72 ore ctre ntreprinderile de
prelucrare. Acest aspect are implicaii economice pozitive, cu obligaia recoltrii laptelui n
condiii igienice .
Trebuie remarcat aspectul c n aceast perioad, aciunea bacteriostatic se manifest
mai intens asupra florei nelactice. In mod normal, cam dup 8 ore de la mulgere,
microorganismele din lapte ncep s ia o ascensiune deosebit prin multiplicare, mai ales
cnd. nu se practic rcirea.
[Link] de acidifiere i de coagulare a cazeinei. Dup ncetarea, fazei bacteriostatice,
bacteriile lactice n special, dar i cele de poluare se nmulesc repede. Cu precdere se
nmulesc bacteriile lactice. Acidifierea excesiv a mediului opresc din dezvoltare bacteriile,
lund ascensiune levurile i miceii, care se dezvolt foarte bine n medii acide, Acidifierea
laptelui proaspt, care trebuie privit ca cea mai important alterare a laptelui, se produce
sub aciunea enzimatic hidrolitic bacterian asupra lactozei Microorganismele
hidrolizeaz lactoza n glucoza i galactoz i apoi pe acestea n acid lactic. Dintr-o
molecul de lactoz rezult patru molecule de acid lactic.
Cnd aciditatea laptelui ajunge la pH 4,6, cazeina precipitat, trecnd din forma lichid n
forma de gel Coagularea este ajutat i de faptul c acidul lactic scoate Ca din cazeinatul
de calciu, dnd lactat de calciu, i cazeina liber precipit. Transformarea lactozei n acid
lactic de ctre flora lactic prin hidroliz continu pn cnd aciditatea mediului o stnjenete
n dezvoltare. Din acest moment se dezvolt levurile care se nmulesc i cresc foarte bine
n medii acide.
Tema 10. Microflora laptelui
Coagularea spontan a laptelui proaspt trebuie considerat ca o
alterare, totui coagularea laptelui cu flor lactic selecionat are efecte
conservante asupra laptelui, transormndu-1 n produse cu caliti
nutritive i dietetice superioare (Iaurt, lapte acidofil, chefir etc.).
[Link] de neutralizare. Acidul lactic rezultat din fermentaia bacterian
a lactozei este consumat de ctre levuri. Scderea aciditii d
posibilitatea dezvoltrii florei acido-proteolitice. Se ajunge la un moment
dat cnd acidul lactic este epuizat de levuri sau (i) neutrelizat prin
produii rezultai din fermentaia proteolitic slab a florei acidoproteolitice. Perioada aceasta poate dura cteva zile sau chiar
sptmni.
[Link] de putrefacie. n momentul cnd reacia laptelui a devenit
neutr sau uor alcalin, activitatea levurilor nceteaz, iar flora acidoproteolitic acioneaz n limite restrnse, ncepe s se dezvolte flora
proteolitic de putrefacie care hidrolizeaz proteinele. Cu precdere se
dezvolt bacteriile cazeinolitice. Laptele are aspect, gust i miros
modificat, respingtor, insuportabil.
Tema 10. Microflora laptelui
[Link] patogene din lapte i aciunea lor
Laptele este un excelent mediu de cultur i de protejare pentru multe
microorganisme. Multe bacterii patogene importante (M. tuberculosis, M.
bovis, Brucella, Rickettsia) precum i toate virusurile nu se nmulesc n
lapte. Pericolul acestor germeni depinde de gradul iniial de contaminare a
laptelui, de diluia lui ulterioar, de tratamentele la care este supus, de timpul
trecut pn la consumarea lui i de ali factori. Ali germeni patogeni (S. aureus,
S. pyogenes, E. coli .a.) se pot multiplica n lapte. La temperaturi mai mici de
10-12 C, activitatea celor mai muli germeni patogeni este inhibat; acesta
este sensul rcirii laptelui imediat dup obinere i meninerea lui la temperaturi
joase pn la tratamentul termic. Cnd laptele este produs n condiii neigienice
i nu se rcete imediat, microorganismele contaminate produc acid lactic i
cresc rapid laptele .
Agenii microbieni din lapte provin de la animalul productor de lapte, de
la om sau din mediu. Ei pot fi excretai direct din uger n lapte sau pot proveni
de pe pielea i mucoasele animalului i mulgtorului. Omul poate fi o surs de
contaminare a laptelui n orice verig a procesului de producie, pn n
momentul consumrii. Fazele cele mai critice sunt cele, care urmepasteurizrii
cnd un singur purttor uman poate contamina mari cantiti de lapte.
Varietatea microorganismelor care pot polua laptele produc acestuia, pe lng
aspectele generale enunate, unele modificri de culoare, consisten, gust i
miros. n toate aceste cazuri, laptele este depreciat.
Tema 10. Microflora laptelui
Modificri de culoare. Acestea snt determinate de ctre bacterii
cromogene sau micete. Unele dintre aceste microorganisme (Sarcina
luea,
Bacierium typhiflavum)
sau
unele
levuri
din genul
Saccharomyces elaboreaz pigment galben. Acelai aspect poate fi
ntlnit i n cazul contaminrii laptelui cu Pseudomonas care
elaboreaz pigment numai n mediul alcalin. Culoarea neagr este
determinat de dezvoltarea n lapte a lui Bacteriuni lactis niger sau
miceilor Cladosporium herbarum, Torulopsis .sp, Rhizopus. Laptele
albastru este datorat dezvoltrii lui Pseudomonas syncyanea, Bacterium
caeruleum i Bacierium indigonaceum. Ultimele dou elaboreaz o
substan colorat ce deriv din acidul lactic, colornd iniial laptele acid
n albastru, iar cel alcalin n rou. Lapte rou este determinat n primul
rnd de Brevibacterium lactis erytrogenes care produce un pigment la
ntuneric i numai n mediul neutru sau alcalin. Acesta peptonizeaz
cazeina i coloreaz lactoserul n rou. Aceeai culoare roie sub form
de pete roii la suprafaa laptelui mai poate fi determinat de
Chromobacterium spp.
Brevibacterium sp, Serratia marcescens,
Mycrococcus sp. i unele levuri.
Tema 10. Microflora laptelui
Modificri de consisten. Microorganismele pot aciona
sub raportul consistenei n trei direcii, cnd apare lapte filant
sau vscos, lapte necoagulabil i lapte care coaguleaz fr
a fi acid. Laptele vscos sau filant are aspect mucilaginos,
cu precdere la suprafa. Se produce sub aciunea:
streptococilor lactici care i-au pierdut capacitatea de a
produce acid lactic, a lui Propionibacterium freudenreichi care
produce mucine, a lui Bacterium lactis viscosus i
Enterobacter aerogenes, bacteriilor coliforme, Alcaligenes sp.
lactobacteriilor mucogene, germenilor mastitici. Laptele
necoagulabil se ntlnete atunci cnd acestea a fost
invadat de la nceput de flora proteolic, care hidrolizeaz
cazeina, fr a se produce acidifierea laptelui. Laptele care
coaguleaz fr acidifierea corespunztoare apare n
urma contaminrii acestuia cu bacterii din genul Micrococcus,
care secret enzime analoage chimozinei .
Tema 10. Microflora laptelui
Modificri de gust i miros. Laptele amar apare sub aciunea lui
Micrococcus freudenreichi, Bacterium lactis viscosus, Enterobacter
aerogenes. Gustul amar mai poate apare i din cauza bacteriilor
peptonizate i apariiei de acid butiric n lapte, prin aciunea lipolitic a
unor microorganisme. Gustul i mirosul de spun apar cnd laptele
a fost pstrat un timp ndelungat la + 10C i este determinat de
dezvoltarea unor germeni psichrofili care produc n lapte compui
alcalini ce saponific grsimile. Un reprezentant al acestor bacterii este
Bacterium lactis saponacei.
Laptele cu gust i miros de napi este determinat de dezvoltarea n
lapte a unui varieti de Escherichia coli. Laptele cu gust i miros de
fragi apare sub aciunea lui Pseudomonas fragiae.
Laptele cu miros i gust de mal este determinat de aciunea lui
Streptomyces lactis. Acest microorganism descompune leucina i
izoleucina n aldehid izovalerianic. Gustul i mirosul de mucegai
i putrid se observ la lapte proaspt pstrat n recipiente ermetic
nchise. Apare sub influena dezvoltrii unor micei, dar cu precdere a
unor bacterii din genul Alcaligenes i Escherichia.
Laptele cu modificri de culoare, consisten, gust, miros nu se admite
n consum. Se poate valorifica n hrana animalelor, cu condiia fierberii
prelungite n prealabil.
Tema 10. Microflora laptelui
Microorganismele patogene din lapte pot avea dou surse:
1. microorganisme ce ajung de la om n lapte ,
2. microorganisme ce ajung de la animale n lapte.
Printre microorganismele ce ajung de la om n lapte pe primul plan se situeaz
bacteriile tifice, reprezentate de Salmonella paratiphy, Salmonella
[Link] ajung n lapte de la purttorii umani, din ap sau prin
manipulri neigienice.L a fel n lapte poate ajunge i agentul difteriei umaneCorynebacterium diphteriae, Streptococcus pyogenes.n zonele endemice de
holer, laptele poate fi contaminat de om cu Vibrio cholerae.
Transmiterea i rspndirea germenilor patogeni de la animale la om prin lapte
este legat de boli generale sau locale ale [Link] bolile bacteriene se
nscriu:
Tuberculoza produs de Mycobacterium [Link] n lapte poate
avea origine mamar sau extramamar.n cazul originii mamare, se consider a fi
foarte periculos laptele vacilor cu mamit [Link] actul mulsului bacilii
trec din snge n [Link] prioritar eliminarea germenilor se face n cazul
[Link] lui Mycobacterium tuberculosis n lapte este relativ [Link]
rmne viu 14 zile n iaurt, 18-21 zile n laptele acru, 21 zile n unt, n brnzeturi
50-230 [Link] se pot gsi i n laptele pasteurizat
Tema 10. Microflora laptelui
Bruceloza produs de Brucella abortus se elimin prin [Link]
este nsoit de avort la vaci, stare de bacteriemie i eliminarea
germenilor prin lapte i scurgerile vaginale [Link] se elimin
prin lapte un timp ndelungat de 7-8 ani, sau practic brucelele se pot
elimina prin lapte toat viaa economic a vacilor.
Viabilitatea brucelelor n laptele proaspt dureaz 7-9 zile.n laptele
acidifiat brucelele rezist circa 9 zile, n iaurt 8 zile, n kefir 9 zile, n
brnz proaspt de vaci-24 zile, ca-35 zile, unt-50 zile.
Antraxul constituie surs de infectare a [Link] Bacillus anthracis
n lapte se gsete n mod [Link] la om prin consum de lapte
contaminat a fost descris si s-a constatat c n antrax se produc i
mamite acute i chiar [Link] contaminat devine apos, glbui,
srac n grsimi i uneori cu caracter sangvinolent.
Prin lapte se transmit infeciile: salmonelozele, listerioza, botulismul,
pasteureloza, streptocociile i stafilocociile animalelor etc.
Tema [Link] produselor lactate
[Link] produselor lactate acide.
Laptele acidofil se prepar din lapte de vac pasteurizat la 85-90C
timp de 10-15 [Link] se rcete la circa 42C i se
nsmneaz cu o maia ce conine o cultur pur de Lactobacillus
[Link] bacterie are origine intestinal i este foarte uor
activat n [Link] folosete o su rezistent la [Link]
pentru acest produs poate conine dou tipuri de [Link]; unul
care produce un coagul filant i aciditate [Link] ntre
bacteriile nefilante i filante este de 80% i respectiv 20%.
Chefirul reprezint un produs acido-alcoolic, n care se realizeaz o
fermentaie lactic i una alcoolic, cu formare de dioxid de carbon,
care-i d un aspect spumos, cu fine bule de gaz.
Laptele se pasteurizeaz i se rcete a 18-24C i se nsmneaz
cu o maia special n proporie de 5-10%.Maiaua se prepar cu
ajutorul granulelor de [Link] granule snt constituite din particule
de cazein, care conin pe suprafa i n interiorul lor
microorganismele din [Link] aparin bacteriilor
i [Link] acestea specificm: streptococi i bacili lactici; levuri (
Saccharomyces kefiri) i bacterii acetice care produc fermentaie
mixt acido-alcoolic. Bacili peptonizani ai cazeinei ( Bacillus
caucasicus).Maiaua de producie folosit trebuie s fie maturat circa
dou zile la temperatura de 6-8C, timp n care i formeaz aroma.
Tema [Link] produselor lactate
Dup nsmnare laptele este repartizat n [Link] pentru
fermentare se face n [Link] n prima treapt se face la
18-20C, timp de 16-20 ore.n aceast faz se realizeaz acidifierea
laptelui.n faza a doua termostatarea se efectueaz la 8-10C timp de 1-3
zile.n aceast perioad se realizeaz maturarea chefirului, adic
producerea de alcool, dioxid de carbon i hidroliza parial a proteinelor.
n raport de meninere la a doua termostatare pentru maturarea
chefirului, se obin trei categorii de chefir: slab- de o zi cu 0,2% alcool;
mijlociu- de dou zile cu 0,4% alcool; tare- de trei zile cu 0,6%
alcool.
Chefirul normal i de calitate corespunztoare prezint un coagul fin, cu
bule mici de CO2, gust i miros plcut acrior, rcoritor,
[Link]-chimic chefirul trebuie s corespund indicatorilor, s
conin alcool minimum 0,1%.Bacteriologic chefirul trebuie s fie liber
de germeni patogeni.
Tema [Link] produselor lactate
[Link] untului
Substratul nutritiv de baz pentru o bun parte din bacterii, reprezentat de
proteine i hidraii de carbon, este slab reprezentat n unt. Cu toate acestea, n
unt se pot dezvilta unele bacterii, care pot produce modificri de culoare,
consisten, gust, miros. n unt se pot dezvolta levuri i micei care produc la
fel, devieri ale caracterelor normale ale untului.n acest produs se pot dezvolta
microorganismele lipolitice i cel heterofermentative.
Prin contaminarea cu unele bacterii cromogene i micei, pot aprea pe unt
zone colorate sub form de pete, puncte sau difuz.
Petele albastre pot fi determinate de Pseudomonas syncyanea i de
Penicillium [Link] alb sub form de puncte sau pete este dat
de coloniile de Torulopsis, Penicillium, Fusarium etc. Culoarea brun-difuz,
brun-negricioas sau chiar neagr se ntlnete n cazurile contaminrii cu
genurile Alternaria, Mucor, Penicillium [Link] galben intens apare n
contaminrile cu Micrococcus luteus, Sarcina flava dar poate fi dat i de
Saccoharomyces. Petele cenuii pe suprfaa untului snt date de Mucor, dar
uneori acest micet poate determina i o coloraie cenuie [Link] micei ca
Cladosporium, Fuzarium, Alternaria etc. Duc la apariia unor pete [Link]
negre cenuii superficiale sau profunde n unt, snt determinate de
Pseudomonas nigrifaciens, Alternaria, Cladosporium etc.
Culoarea galben-portocalie difuz n unt se ntlneste n contaminari
masive cu Aspergillus, Penicillium [Link] aseti micei, prin dezvoltare, dau
aspect de pete portocalii pe unt, iar Saxxharomzces poate da pe unt culoarea
portocalie nsoit i de mucilagiu.
Tema [Link] produselor lactate
Culoarea roie diferit nuanat, poate fi determinat, att de bacterii, ct i de
[Link] petele roii snt determinate de Serratia, Micrococcus, Fusarium i
[Link] de rou-cpun sub form de pete sau cuiburi este dat de
dezvoltarea bacteriei Serratia marcescens, iar culoarea roie-murdar difuz de
Micrococcus roseus sau de ctre Mucor racemosus. Torulopsis poate determina
o culoare [Link] difuz a untului poate fi dat de miceii din genurile
Penicillium, Aspergillus, Alternaria, Cladosporium.
Ca modificri de consisten a untului, produse de microorganisme,
specificm untul filant, care se spal foarte greu, conine o cantitate mare de
proteine i are gust de brnz. Cauzele snt multiple:
Intervenia unor mutante de [Link] i [Link], a unor tulpini maltigene de
Str. Lactis sau a bacteriilor din genurile:Micrococcus, Pedococcus, Lactobacillus
casei etc.
Intervenia bacteriilor coliforme sau a genurilor Alcaligenes, Proteus, Bacillus,
Pseudomonas.
Consistena uleioas a untului poate fi determinat de germenii psichrotrofi.
Microorganismele pot produce n unt devieri ale gustului i mirosului, prin
aciuni enzimatice, glicolitice, proteolitice, lipolitice sau prin aciuni enzimatice
[Link] procese de glicoliz la intervenia bacteriilor coliforme, a levurilor
i a unor bacterii proteolitice, untul capt gust acru, acru-brnzos sau acrudrojdios.
Tema [Link] produselor lactate
Prin procese de proteoliz n unt se pot ntlni devieri de gust i miros traduse
prin:
Apariia de gust i miros de caramelizat determinate de contaminri ale
smntnii pentru unt cu mutant ale lui Str. Lactis, Lactobacillus maltaromicus,
unele bacterii acidoproteolitice din genurile Micrococcus, Flavobacterium,
Proteus, Pseudomonas, Bacillus, Seratia i unele drojdii ca Torulopsis.
Apariia de gust amar, determinat de peptonele rezultate din hidroliza
enzimatic bacterian a proteinelor, de ctre bacteriile peptonizante sau de
ctre levuri, dintre care specificm micrococi, bacteriile coliforme etc.
Apariia unui gust brnzos, diferit nuanat, determinat de bacterii, levuri i
mucegaiuri ca bacteriile coliforme, micrococi, Proteus, Alcaligenes,
Pseudomonas, Candida lipolitica, Penicillium, Aspergillus etc.
Apariia de miros fetid i dizgraios, determinat de contaminri masive cu
micei din genurile Micoderma, Torulopsis etc.
Apariia de miros de grajd i apoi a gustului amar, determinat de bacteriile
coliforme.
Perceperea unui gust i miros de sfecl determinat de bacteriile coliforme,
Pseudomonas, Penicillium etc.
Apariia unui gust i miros de varz n unt este dat de bacteriile coliforme.
La intervenia enzimelor lipolitice alr genurilor Enterobacter, Serratia,
Corynebacterium, Micrococcus, Flavobacterium, Bacillus se produce hidroliza
gliceridelor, imprimndui un gust de oxidat, [Link] poate fi indus i de
activarea enzimelor lipolitice la intervenia luminii, temperaturii i metalelor
grele.
Tema [Link] produselor lactate
Gustul de ulei mineral este determinat de enzimele lipolitice i proteolitice ale
lactobacililor, bacteriilor coliforme i altor bacterii proteolitice.
Gustul de pete poate fi determinat de enzimele lipolitice termostabile, provenite
din contaminri ale untului cu [Link], [Link], [Link], bacterii
coliforme. Aceste microorganisme descompun complexul lecitino-proteic al
membranei globulei de grsime, elibernd lecitina, care prin oxidare va da
trimetil-amin, responsabil de gustul derivat.
Alterrile untului se nscriu prin modificri ale compoziiei la intervenia
bacteriilor, miceilor i factorilor [Link] aceste cauze conduc la
alterarea cea mai important a untului rncezirea.
Se consider c 30% din alterrile untului snt determinate de cauze
microbiologice, 30% din cauze fizico-chimice i 40% din cauze mixte, adic
microbiologice i fizico-chimice.
Rncezirea se desfoar n etape i anume:
-hidroloza gliceridelor n acizi grai i glicerin, proces indus de unele bacterii,
levuri, micei sau prezena fazei apoase;
-oxidarea acizilor grai saturai este indus n general de levuri i micei, iar
oxidarea acizilor grai nesaturai este indus n principiu de factorii fizico-chimici;
-lumina, oxigenul, atmosferic i temperatura
Tema [Link] produselor lactate
Majoritatea bacteriilor nu realizeaz dect faza hidrolitic, pe cnd drojdiile i
mucegaiurile, pe lng faza hidrolitic, induc i faza oxidativ.
Dintre bacterii primeaz genurile Baciilus, Pseudomonas, Alcaligenes,
Serratia, Flavobacterium, dintre micei genurile Penicillium, Cladosporium,
iar dintre levuri genurile Candida, Rhodotorula.
Faza de lipoliz hidrolitic poate fi indus de bacterii din genurile Micrococcus,
Corynebacterium, Flavobacterium, bacterii coliforme i de micei din
genurile Penicillium, Candida.
Lipoliza hidrolitic sau alternativ hidrolitic i oxidativ poate fi indus de
genurile Baciilus, Pseudomonas, Mucor, Aspergillus, Penicillium,
Cladosporium etc.
Oxidarea acizilor grai saturai cu formarea de metil cetone, oxidare cunoscut
sub denumirea de rncezire cetonic sau parfumat este indus la intervenia
prioritar a mucegaiurilor din genurile Penicillium, Aspergillus, Fusarium,
Mucor, Dematium, Alternaria etc.
Oxidarea acizilor grai nesaturai aprui dup procesul de hidroliz este de
natur catalitic, rezultnd ntre produii finali i aldehide; ea este denumit de
rncezire aldehidic.
Tema [Link] produselor lactate
Sub raport microbiologic, untul trebuie s fie liber de microorganisme
[Link] patogene din unt pot avea dou origini:
de la animalele bolnave ( deci din laptele recoltat de la aceste animale)
i din contaminri ulterioare ale laptelui sau ale smntnii prin neglijene
igienice.
Folosirea unei smntni nepasteurizate sau ineficient pasteurizate la
fabricarea untului d posibilitate existenei n unt a unor microorganisme
patogene, originare din lapte de la animalele bolnave.n aceste
mprejurri n unt se pot regsi: Mycobacterium tuberculosis, Brucella
abortus, Salmonella etc.
n procesul tehnologic de fabricaie, att smntna pentru unt, ct i
untul ca atare, pot fi contaminate cu germeni patogeni de ctre unele
persoane purttoare de germeni, sau prin neglijene igienice.
n unt aceste microorganisme pot supravieui un timp ndelungat i prin
consumul untului contaminat pot produce [Link] care conine
asemenea microorganisme se scoate din consum.
Tema [Link] produselor lactate
[Link] brnzeturilor.
Brnzeturile snt produse lactate obinute prin coagularea cazeinei din lapte, care reine
n majoritate grsimile, o parte din lactoz i srurile minerale.
Alterrile microbiene din brnzeturi se dezvolt n cazul dezvoltrii florei proteolitice
de putrefacie.n rezultat brnza capt gust i miros [Link] se ntlnete la
brnzeturile la care srarea nu s-a fcut suficient, sau la care s-a scurs [Link]
bactreiile de putrefacie peptonizeaz cazeina, dndgust amar brnzei. n ambele cazuri,
brnza se exclude din consum.
Unele bacterii cromogene prin dezvoltarea lor n brnz imprim culori diferite sub form
de zone colorate pe coaj sau n miezul [Link], culoarea roie brun poate fi
determinat de dezvoltarea lui Bacterium, acizi propionici, Micrococcus [Link]
portocalie sau roietic poate fi determinat de Micrococcus [Link] albastr
poate fi determinat de dezvoltarea lui [Link].
Balonarea precoce sau timpurie a brnzei este o alterare produs n majoritatea
cazurilor 80% de Enterobacter aerogenes i ntr-o mai mic msur de [Link]
brnzei se produce repede sub pres, n timpul srrii sau la cteva zile de la fabricare.
Brnza este improprie pentru consum i se [Link] acestei alterri se face
prin folosirea unui lapte igienic i a unor maiele active.
Balonarea trzie apare dup circa 10 zile de la fabricarea pn la dou [Link]
este determinat de Clostridium tyrobutyricum care transform lactaii n butirai,
propionai, CO2 i H2.
Masa brnzei apare umflat consecutiv apariiei unor ochiuri mari de fermentaie
delimitate de past foarte [Link] are un accentuat miros i gust butiric i se
confisc.
Tema [Link] produselor lactate
Putrezirea alb este mai frecvent ntlnit i este
determinat de Clostridium [Link] dezvoltarea
acestui germen se produc modificri ale unor zone din
brnz, n care pasta are culoare foarte alb, o consisten
foarte moale, un miros respingtor i un gust putrid.
Putrezirea alb este cunoscut sub denumirea de
cancerul [Link] lui Clostridium
sporogenes este favorizat de creterea pH-ului n timpul
maturrii i de meninerea brnzei n spaii prea
[Link] cu putrezire alb se confisc.
Putrezirea cenuie este produs de Bacterium
proteolyticum i apare la dou-cinci luni de la fabricarea
[Link] devine gri-albstruie i este presrat
uneori cu puncte negre care reprezint coloniile de
[Link] brnza are miros fecaloid
respingtor, ca apoi dup 1-2 luni s aib un miros de
usturoi sau [Link] cu putrezire cenuie se confisc.
Tema [Link] produselor lactate
Mucegirea brnzeturilor este determinat de prezena mucegaiurilor
care se dezvolt n rezultatul mediilor prielnice de [Link]
frecvent miceii se dezvolt pe brnzeturile care nu sunt protejate de
[Link] tari, protejate de coaj, snt mai rar [Link] se
dezvolt superficial pe brbzeturi, dar uneori se pot dezvolta i profund.
Prin dezvoltarea pe suprafaa brnzei a micetului Scopulariopsis
brevicaulis se formeaz un strat alb de aspect finos dat de dezvoltarea
conidiilor. Pete de culoare galben, reprezentnd coloniile de micei pot
apare pe brnzeturi cnd se dezvolt Oidium aurantiarum.
Pete sau zone de culoare negricioas albstruie se pot identifica pe
brnzeturi cnd se dezvolt Oidium niger, Aspergillus niger i ali micei.
Principala alterare fizico-chimic a brnzeturilor este rncezirea
grsimilor ce le [Link] de rncezire este ajutat mult de miceii
care contamineaz brnzeturile.
Tema [Link] produselor lactate
Microorganismele patogene din brnzeturi se caracterizeaz prin prezena de germeni
patogeni, care ar putea produce la consumatori infecii sau toxiinfecii alimentare.
Contaminarea brnzeturilor cu astfel de germeni se poate realiza:
De la materia prim provenit de la animalele bolnave;
n timpul prelucrrii , de la utilaje infectate;
n timpul prelucrrii de la persoanele bolnave, mute, gndaci, condiii igienice deficitare;
n timpul maturrii i pstrrii de la persoanele bolnave, roztoare, condiii igienice
deficitare.
Rolul stafilococilor, streptococilor i coliformilor n producerea de toxiinfecii alimentare la
om este deosebit.
Staphylococcus aureus se dezvolt bine n brnzeturile srate i elaboreaz
enterotoxine. Pasteurizarea laptelui duce la omorrea germenilor, dar enterotoxina nu este
distrus, fiind termorezistent.
Streptococii din grupa D au fost izolai din [Link] pot determina toxiinfecii
alimentare la om.
[Link] a fost deasemenea incriminat n producerea de toxiinfecii alimentare la unele
persoane prin consum de brnz proaspt de [Link] acestui germen n lapte este
prioritar de origine fecal i rmne viu i n brnzeturi, putnd produce att alterarea brnzei,
ct i n raport de originea contaminrii i serotip- toxiinfecii alimentare la consumatori.
Tema [Link] produselor lactate
n declanarea tulburrilor la consumatori intervin trei factori: exotoxina
neurotoxic; endotoxina enterotoxic; produii toxici nespecifici ( indol, scatol,
fenol etc).
Clostridium botulinum a fost de asemenea ntlnit n brnzeturi care a provocat
mbolnviri grave la om.
Coxiella burneti rezist la aciunea labfermentului.n mod practic brnza rmne
infectat cel puin 17 zile de la fabricaie.
Brucelele dup unii cercettori, rezist n brnzeturile preparate cu cheag un
timp de 45 zile.
Mycobacterium bovis rmne viu n brnzeturi un timp relativ mare.n
brnzeturile rneti acesta rmne viu pn la 60 de zile. n brnzeturile moi,
[Link] rmne viu un timp ndelungat. Practic, viabilitatea lui [Link] nceteaz
n faza de maturare, cnd are loc un proces intens de proteoliz. n brnzeturile
tari ca brnza vaier [Link] rezist circa 30 de zile. [Link] poate supravieui n
brnzeturile cu fermentaie lent pn la 240 zile.
Salmonella rezist de asemenean brnzeturi o perioad de timp legat de modul
de preparare a brnzeturilor. Salmonella typhimurium rmne vie n brnz circa
50 de zile. [Link] i [Link] rmn vii n cacavaluri timp de 4-20
zile, dependent de faza de oprire i aciunea inhibitoare a srii i
microorganismelor lactice.
Tema [Link] produselor lactate
[Link] smntnii
Smntna este produsul obinut prin separarea laptelui n dou pri. O
plasm mbogit n grsime- smntna, i retsul plasmei cu un coninut
redus n grsime- laptele smntnit.
Smntnirea laptelui se poate realiza natural i mecanic.n industrie
smntnirea se face mecanic cu ajutorul separatoarelor mecanice care se
bazeaz pe principiul forei centrifugale.
Pentru obinerea unei smntni de calitate se cere ca laptele s fie de
bun calitate, adic s aib densitatea minim 1,028, grsimea minimum
3,2%, aciditatea maxim 20T i gradul de curenie 1.
Laptele supus smntnirii mecanice trebuie s fie nclzit la 40-45C.
Industrial smntna se obine prin urmtoarele procese tehnologice:
Obinerea smntnii dulci prin degresarea laptelui n separatoare i
aducerea ei la procentul de grsime cerut de sortimentul respectiv , prin
reglarea separatorului sau prin normalizare;
Tema [Link] produselor lactate
Pasteurizarea smntnii obinute la temperaturi foarte nalte n timp scurt 90-95C
sau pasteurizarea prin injectare direct dee vapori de ap;
Rcirea smntnii la 18-22C, n vederea nsmnrii cu maia;
nsmnarea cu maia n proporie de 5% pentru fermentare.
Maiaua conine dou categorii de microorganisme lactice: acidifiante
[Link],
[Link]
i
aromatizante
Leuconostoc
citrovorus,
Leuconostoc paracitrovorus.
Maturarea biochimic care se realizeaz n vase speciale la temperaturi de 1416C, timp de 8-10 [Link] ntrerupe fermentaia cnd aciditatea global ajunge la
60-70T.
Ambalarea, care se face n pungi sau pahare i rcirea la +4 sau +8C .
Smntna astfel obinut se prezint ca o mas omogen, vscoas, fr
aglomerri, fr impuriti, de culoare alb sau glbuie, cu gust plcut acrior i
cu arom specific.
Defectele smntnii pot fi:
Originare
Ctigate
Printre defectele primare sau originare se pot enumera: gustul i mirosul de
furaje transmis smntnii de ctre lapte; gustul amar apare n urma furajrii vacilor
cu nutre ru nsilozat sau n urma ingestiei de plante ce conin substane amare.
Tema [Link] produselor lactate
Printre defectele ctigate n cursul prelucrrii, n prim plan se nscriu:
gustul fad sau lipsa aromei determinat de insuficiena fermentrii, la
temperaturi neadecvate sau folosirea unei maiele inactive; gustul prea
acru se obine cnd fermentaia este prelungit sau se face la
temperaturi mai ridicate i cnd nu se rcete la pstrare n mod
corespunztor; gustul i mirosul de ambalaj sau metalic este produs de
vasele nepregtite corespunztor sau de prezena cuprului sau ferului
provenit de la vase sau instalaii.
Gusturi i mirosuri strine se pot ntlni i n situaii cnd nu se respect
parametrii tehnologici de pasteurizare i fermentare, cnd pot lua natere
unii produi volatili cu mirosuri diferite. Grsimea din smntn absoarbe
toate mirosurile strine de la alte alimente, depozit etc.
Ca defecte de consisten se ntlnesc: smntna prea fluid ca
rezultat al maturrii insuficiente; smntn vscoas etc.
Tema 12. Microflora crnii
[Link] de contaminare bacterian a crnii
Gradul de contaminare bacterian a crnii depinde de o suit de factori ntre care se
nscriu:
Starea igienic a animalelor n ferme, a alimentaiei, a transportului i ntreinerii n bazele
de animale;
Starea fiziologic;
Starea sanitar-veterinar;
Starea igienei corporale n momentul sacrificri;
Starea igienei generale a ntreprinderii de tiere;
Igiena fluxului tehnologic.
Toi aceti factori vor influena negativ calitatea igienic a crnii, cnd nu se va respecta
cerinele igienice severe reclamate de fiecare din factorii care condiioneaz starea igienic
primar a crnii.
Sursele de contaminare a crnii i organelor cu microorganisme snt legate de:
-animalul destinat tierii i
-de condiiile igienice de prelucrare.
Contaminarea crnii legat de diverse surse poate fi:
-intravital
-postvital
Tema 12. Microflora crnii
Contaminri intravitale se ntlnesc n anumite stri fiziologice i patologice.
Starea fiziologic a animalului n momentul sacrificrii are o importan
deosebit. La animalele obosite, epuizate, flora intestinal traverseaz peretele
intestinal, ajunge n ganglionii limfatici, limf i snge.
Ph-ul ridicat al acestei crni favorizeaz nmulirea bacteriilor i reduce
conservabilitatea ei.
La animalele n plin digestie, din cauza congestiei intestinale i creterii
permeabilitii intestinului, germenii din tubul digestiv ptrund n limf i [Link]
fel, acest fenomen se observ i la animalele nfometate, prost ntreinute.
Odat cu flora banal din intestin pot ptrunde i germeni foarte periculoi din
genul [Link] sacrificare acetea ns rmn, influennd negativ
conservabilitatea i salubritatea crnii.
Stare de sntate a animalelor are o influen [Link] animalele bolnave
de boli bacteriene, microorganismele se pot gsi n toate esuturile sau numai n
unele, n raport de boal i tipul evoluiei.
Starea de igien corporal a animalelor n momentul tierii are o importan
deosebit.
Cu ct animalele snt mai murdare, cu att se mresc ansele de contaminare a
suprafeelor carcaselor de pe exteriorul pelii.
Tema 12. Microflora crnii
Cele mai frecvente suprafee de contaminare bacterian la animale snt
urmtoarele: suprafaa pielii cu produciile ei, a tractusului gastrointestinal,
a mucoasei nazofaringiene, oculare i a prilor terminale ale cilor
[Link] ct aceste suprafee de tegument i mucoase vor fi mai
contaminate bacterian, cu att posibilitile de contaminare a crnii n timpul
prelucrrii animalelor vor fi mai mari.
Cercetrile au demonstrat c bacteriile ntlnite pe suprafeele carcaselor snt
identice cu cele de pe pielea animalelor i din tubul lor digestiv, care la rndul lor
snt identice cu cele din sol, ap, furaje.
Pentru limitarea contaminrii suprafeei carcaselor, se impune asigurarea unor
condiii igienice prin meninerea lor curat n ferme, pe timpul transportului i n
bazele de animale ale abatoarelor.
Reducerea ncrcturii bacteriene a suprafeei tegumentului se poate realiza la
unele specii prin splarea animalului nainte de [Link] de splare nu se
poate aplica la oi.
Cu ct pielea i produciile piloase voe fi mai intens murdrite cu diferite impuriti
i fecale, cu att posibilitile contaminrii carcaselor snt mai mari n timpul
jupuirii.n aceste situaii numrul total de germeni pe 1cm a suprafeei carcasei
poate ajunge pn la 100000 [Link] rol important n contaminare l au
cuitele de jupuire care vehiculeaz un numr mare de germeni i minile
muncitorilor care nu respect igiena n timpul lucrului.
Tema 12. Microflora crnii
Contaminarea bacterian a crnii n timpul prelucrrii se rezum la diverse
operaiuni tehnologice neglijente, executate manual, conduc n mod inevitabil la
contaminarea crnii.
Contaminarea crnii se poate face n timpul [Link] se realizeaz prin
absorbia sngelui contaminat de ctre vene aflate sub presiune [Link]
la rndul lui se contamineaz de la piele, utilajele i instrumentele folosite la
desngerare.
Contaminarea bacterian la jupuire are o importan [Link] se realizeaz
cu ajutorul instrumentelor de jupuit, minile muncitorilor, echipamentul de protecie
murdar [Link] n condiii neglijente, cu instrumente murdare, mini murdare
i contactul carcasei cu partea extern a pielii conduc la o poluare bacterian
intens a crnii.
Contaminarea bacterian cu coninutul ruminal, stomacal i intestinal a
carcaselor se produce cnd aceste organe se secioneaz sau se sparg din
neglijen i cnd nu se practic lrgarea lor prin lrgturi duble la locurile de
segmentare la [Link] cunoscut faptul c n tubul digestiv al
animalelor se gsete cea mai numeroas i periculoas flor
[Link] crnii prin coninut din cile digestive conduce la o
contaminare intens a ei pe locurile [Link] lng flora banal, n tubul
digestiv se pot gsi i microorganisme patogene periculoase pentru om cum sunt
salmonelele.
Tema 12. Microflora crnii
Contaminrile carcaselor cu microorganisme din tubul digestiv se realizeaz i
cnd flora microbian intestinal traverseaz pereii intestinali, invadnd organele
i carcasa.
Alte surse de poluare sunt legate de starea igienic a ntreprinderii de
[Link] unitii de tiere depinde de o serie de factori, dintre care mai
importani snt: amplasarea, tipul construciei i al materialelor de construcii,
sistematizarea, fluxul tehnologic, gradul de utilare i de dotare, condiiile create
pentru meninerea cureniei etc.
Orice neglijen n pstrarea unei stri igienice corespunztoare se reprezint
negativ asupra crnii, crendu-se posibiliti de contaminri [Link] la
poluarea crnii, n proporiee mai mic, microorganismele n suspensie din
atmosfera abatorului.O nsemntate deosebit o are ns transportul i
depozitarea.
La poluarea crnii particip:
- pielea i murdria animalelor 33%, aerul atmosferei abatorului 5%, transportul i
depozitarea 50-54%, ambalarea 2%, alte surse 3%.
Microflora de poluare este reprezentat de: coci grampozitivi( streptococi,
stafilococi), bacili gram pozitivi de tipul lactobacililor, bacili aerobi
sporigeni Bscillus mezentericus, [Link], [Link] etc., bacili gram
negativi [Link], Proteus vulgaris, salmonele etc., bacili anaerobi sporigeni
Clostridium septicus, [Link], [Link] etc.
Tema 12. Microflora crnii
Pe lng flora artat mezofil, se pot ntlni i specii de bacterii psihrotrofe i
criotolerante ca Pseudomonas aeruginosa, [Link] etc.
Nu poate fi neglijat nici microflora de poluare, reprezentat de levuri, micei
filamentoi, care pot interveni n dinamica desfurrii procesului de putrefacie.
Un aspect aparte l reprezint poluarea crnii cu germeni din genul Salmonella.
[Link] de reducere a contaminrii crnii cu microorganisme
Pentru realizarea acestui proces se poate activa n trei direcii:
Condiionarea i pregtirea corect a anomalelor pentru tiere
Asigurarea unor fluxuri tehnologice i sanitar veterinare corecte
Asigurarea celor mai severe condiii de igien general a unitii de tiere
Pregtirea animalelor cuprinde: odihn, ntreinerea , dieta, adparea i
toaletarea prin splare a [Link] cerine, cnd sunt respectate i corect
conduse, duc nemijlocit la reducerea posibilitii de contaminare a crnii i
organelor.
Se recomand ca desngerarea s se fac n poziie [Link] imediat
dup detaare se vor spla cu ap sub presiune i se vor [Link] de
prejupuire i jupuire mecanic se va face atent, ngrijit i n perfecte condiii de
igien.
Tema 12. Microflora crnii
Splarea carcasei se va face n trepte ncepnd de la partea
superioar spre partea [Link] pieilor i prului din sala
de tierea trebuie fcut imediat, iar supravegherea atent a cureniei
personalului, a instrumentelor i a fiecrui loc de munc are o
importan deosebit n reducerea gradului de poluare a crnii i
organelor.
La suine modul prelucrrii are influen deosebit asupra gradului de
poluare a crnii.
Carnea porcilor prelucrai jupuii este totdeauna mai poluat bacterian
dect n cazul opririi i prlirii.
Prlirea are i ea un efect pozitiv, ducnd la reducerea numrului de
microorganisme de pe suprafaa carcaselor porcilor.n procesul opririi
are loc distrugerea formelor vegetative ale bacteriilor i ale salmonelei
n special.
Alt factor n reducerea contaminrii bacteriene a crnii este gradul de
igien general, dotarea cu instalaii i utilaje pentru splat i sterilizat,
ntreinerea corespunztoare a utilajelor, instrumentelor i obiectelor.
ntreinerea igienic a utilajelor, n special care vin n contact cu
carnea, este o cerin de baz.
Tema 12. Microflora crnii
[Link] infecioase ale animalelor de mcelrie.
Bolile transmisibile de la animale la om poart denumirea de zoonoze.
Dei termenul este impropriu, desemnnd boli animale i nu boli transmisibile de
la animale la om, el este foarte important i consacrat oficial pe plan
[Link] zoonozelor cunoscute azi este foarte mare, ridicndu-se la
circa 150, din care aproape 100 snt determinate de bacterii, riketsii,
[Link] cu caracter infecios aparin ortozoonozelor, metazoonozelor
i saproozoonozelor.
Cile de transmitere a bolilor infecioase de la animalele bolnave la om se
realizeaz prin:
Contactul direct al omului cu animalele bolnave sau purttoare de germeni;
Contactul cu obiecte contaminate de animale bolnave;
Manipularea cadavrelor, crnurilor, organelor etc. Provenite de la animalele
bolnave;
Consumul de alimente de origine animal provenite de la animale bolnave care
nu au fost salubrizate sau au fost contaminate ulterior;
nepturi de cpii i insecte hematofage.
Bolile infecioase transmisibile la om au importan prin gravitatea lor i se
transmit prin contact cu animalele bolnave sau prin produsele i subprodusele
rezultate n via sau dup tiere.
Tema 12. Microflora crnii
Printre zoonozele bacteriene se nscriu:
[Link] o bacterioz cu evoluie cronic, comun omului
i multor specii de mamifere, psri, produs de Mycobacterium
[Link] primare de infecie snt reprezentate de animalele,
psrile i oamenii bolnavi, care prezint leziuni deschise ce comunic
cu exteriorul.n timpul tusei, exudatul este proiectat de animalele
bolnave sub form de particule fine, care rmn suspendate n aer i
pot determina mbolnviri la om i animale.
Carnea i organele de la animalele tuberculoase reprezint o surs
important i potenial [Link] animalelor tuberculoase poate
fi virulent, adic s conin bacilii tuberculoi.n caz de tuberculoz se
dau n consum condiionat carnea i organele comestibile, dup o
prealabil sterilizare prin fierbere sau autoclavare.
[Link] boli infecioase produse de germeni din genul
Salmonella, care se manifest clinic prin septicemii, gastroenterite,
avorturi [Link] n prezent se cunosc foarte multe specii de
Salmonella care produc infecii la om, animale domestice i slbatice i
[Link] clinic i morfopatologic este determinat att de toxinele
microbiene, ct i de aciunea virulent a germenilor.n salmoneloze un
rol important prezint examenul [Link] s-au gsit
salmonele numai n ganglionii mezenterici, ficat, vezicul biliar, la
suprafaa organelor sau carcasei se confisc organele, iar carcasa se
d n consum condiionat prin fierbere sau autoclavare.
Tema 12. Microflora crnii
[Link] o bacterioz ntlnit la multe
specii de animale i [Link] este determinat de
Bacillus anthracis, germen aerob, imobil,
capsulat, sporigen.
Fiind o infecie extrem de grav pentru animale i
om, tierea animalelor bolnave de antrax este
[Link] animalelor cu antrax se distrug
prin incinerare.
Morva, turbarea, brucelozele, febra aftoas,
leptospirozele etc. sunt infecii importante
deasemenea care se transmit prin intermediul
produselor din carne la om .
Tema 13. Microflora produselor din carne
[Link] [Link] ale salamurilor.
Mezelurile dup gradul de poluare pot prezenta defecte, degradri i alterri.
Defectele salamurilor apar ca defecte tehnologice, printre care se nscriu:
Salamul [Link] se ntlnete la batoanele rcite brusc, cnd retractarea pastei i a
membranei se face n timp [Link] cu acest defect se pot consuma fr restricii.
Salamul cu membran plesnit, [Link] apare la batoanele la care tratamentul
termic se face la temperaturi mai mari dect cele prescrise sau tratamentul termic este
[Link] cu acest defect nu se pot [Link] pot consuma imediat,
refolosit cu pruden n alte preparate ce se [Link] plesnite se altereaz foarte
repede.
Salamul ru [Link] defect se caracterizeaz prin prezena n compoziie sau sub
membran a unor goluri, determinate de umplerea defectuoas a [Link]
goluri favorizeaz procese de fermentaie i [Link] ce se iau n aceste cazuri snt
determinate de intensitatea defectului i a modificrilor ntlnite.
Salamul cu [Link] apare n cazul uscrii forate, cu apariia unei cruste uscate
superficiale la [Link] depreciaz gustul produsului.
Salamul cu culoare neuniform n seciune dup pasteurizare.n seciune, batonul are
culoare roie marginal i cenuie verzuie n [Link] este cauzat de
neomogenizarea pastei, insuficienei nitriilor, tratamentul termic insuficient.
Tema 13. Microflora produselor din carne
Salamul cu aglomerri de grsime sub membrana i transudri de
[Link] membrana batoanelor se observ depozite de grsime,
care dau aspect neregulat i consisten [Link] batoanele cu
grsime transudat, se observ cantiti mari de grsime pe
[Link] snt determinate de folosirea n produse a unor
cantiti prea mari de grsime moale.
Dezlipirea [Link] se ntlnete la produsele la care
membranele folosite au fost prea vechi, fr a mai avea [Link]
va avea n vedere ca procesul s nu fie dat de alterri.
Decolorarea i nmuierea centrului [Link] este ntlnit la
[Link] lng nmuierea central se observ o cretere a aciditii
sau o acrire a compoziiei.
Prezena de cristale n [Link] apare la salamurile de
durat cu depozitare ndelungat.n masa compoziiei se evedeniaz
aglomerri albe cenuii, [Link] formatew din fosfat disodic
provenit din polifosfaii adugai sau din unele procese biochimice din
carne, ca urmare a deshidratrii [Link] n aceast situaie
se gsete la limita superioar a conservabilitii.
Tema 13. Microflora produselor din carne
Salamul prea [Link] ntlnete la produsele pstrate prea
[Link] are consistena tare, decolorat i prezint uoare devieri
de gust i [Link] se poate comercializa dar la preuri reduse.
[Link] ale salamurilor
Considerm ca degradri ale salamurilor roaderea lor de ctre insecte,
roztoare, prin aciunile mecanice produse asupra preparatelor.
Prin procesul de roadere, insectele pot contamina produsele cu bacterii saprofite,
dar i patogene. n depozitele neigienice se pot ntlni diverse insecte care
atacnd produsele perforeaz membranele i ajung la coninut, pe care.l
infecteaz.n aceste cazuri, dac infestarea este limitat, se extirp zonele
atacate, restul putnd fi dat n consum.
n perioadele clduroase, cnd nu se asigur protecia batoanelor fa de
mutele carnivore, acestea depun oule sau larvele pe batoane, unde se
dezvolt i le degradeaz. n cazul cnd roaderea batoanelor a fost fcut de
roztoare, msurile ce se iau vor ine seama de ntinderea degradrii i de faptul
dac produsele au fost sau nu murdrite de dejecii.n cadrul degradrilor ntinse
i murdririi produselor, acestea se vor confisca.
Tema 13. Microflora produselor din carne
[Link] ale salamurilor
Ca alterri ale salamurilor se nscriu:
ncingerea sau fermentaia [Link] cu fermentaie acid au membrana
i stratul superficial al compoziiei decolorate, miros acru, gust fad i uneori la
ruperea batoanelor se observ filoane de mucus [Link] consider acest
proces la prospturi i semiafumate, fiind indus de flora microbian glicolitic i
glicoproteic.
Salamuri cu mzg i colonii de mucegaiuri pe [Link] se
ntlnete la salamurile ru depozitate, n spaii cu umiditatea relativ ridicat.n
situaia cnd procesul intereseaz numai membrana, fr afectarea compoziiei,
se va proceda la recondiionarea [Link] se va face prin
splare cu o soluie acetic 3% sau cu saramur concentrat.
nverzirea [Link] se ntlnete mai frecvent la parizer i este
indus de [Link].
Salamuri [Link] se recunosc dup modificrile membranei i
procesele proteolitice bacteriene ale compoziiei, cu emanare de miros putrid.
Rncezirea [Link] proces alterativ de natur fizico-chimic se poate
ntlni la salamurile cu pstrare mai [Link] sufer procese de
oxidare, iar produsul are gust i miros rnced.
Tema 13. Microflora produselor din carne
Fermentaia [Link] estre indus de germeni din genul Clostridium,
frecvent fiind incriminat [Link] este bine ntins, consistena
compozoiei moale i crepitant, prezentnd miros putrid i uneori miros
[Link] apare la salamurile prelucrate n condiiile neigienice sau cnd se
folosete carnea cu grad nalt de poluare [Link] n salamuri se poate
dezvolta i [Link], care elaboreaz o toxin extrem de patogen pentru
[Link] bacterie se poate dezvolta i fr producere de [Link]
lng genul Clostridium, poate participa la procesul de umflare a salamurilor i
bacterii din genul Bacillus.
[Link] mezelurilor
Acest control are n vedere:
Examenul organoleptic al produselor privind aspectul exterior al membranei,
aspectul compoziiei fr membran, consistena compoziiei, aspectul n
seciune, gustul, mirosul.
Examenele fizico-chimice privind calitatea prin determinarea procentului de
ap, grsimi, proteine, sare, alte substane adugate.
Examenele fizico-chimice privind prospeimea prin determinarea NH3 slab
adiionat, identificarea NH3 liber, identificarea sulfurii de hidrogen, identificarea
aldehidelor, stabilirea cantitii de nitrii etc.
Tema 13. Microflora produselor din carne
Examenele microbiologice privind starea, care se pot referi la prezena
microflorei saprofite sau microflorei patogene.
Examenele organoleptice trebuie s aib n vedere i respectarea
parametrilor privind dimensiunile [Link] trebuie s corespund
sub raportul diametrului, lungimii, al modului de legare a capetelor, al
mpachetrii cu sfoar a batoanelor grele i de dimensiuni mari i prelucrrii
corespunztoare nainte de umplere a membranelor.
Condiiile microbiologice ale mezelurilor au importan [Link]
pasteurizarea salamurilor, formele sporulate de Clostridium i Bacillus nu sunt
[Link] o termorezisten relativ ridicat, mai ales cnd snt protejate
de grsimi unele specii sau tulpini de streptococi.
Bacteriile gram negative saprofite snt omorte n salamuri dac se respect
regimul de tratament [Link] snt omorte n mod obinuit din
mezeluri, dar n cazuri de subtratare termic, pot [Link] lng
salmonele, n caz de subtratare termic, pot supravieui i bacterii din grupa
coliformilor.
n cazul contaminrii crnii cu [Link], bacteria este n general omort la
pasteurizare, rmnnd enterotoxina n produs care este termostabil.
Pe lng microflora rezidual din salamuri, acestea pot fi contaminate dup
fabricare prin depozitare deficitar, transport, [Link] mod de
contaminare se poate face att cu bacterii saprofite, ct i cu bacterii patogene.
Tema 13. Microflora produselor din carne
Condiiile microbiologice generale ale preparatelor de carne
n membran snt:
Absena germenilor patogeni sau a toxinei botulinice;
Absena germenilor care prin dezvoltare produc indol;
Absena germenilor anaerobi de putrefacie;
Maxumum 10 coci sau bacili gramnegativi n frotiurile de
amprent din profunzime;
Absena mucegaiurilor n profunzime.
Tema 14. Microflora petelui
[Link] petelui cu microorganisme.
Petele prezint o surs de protein animal foarte [Link] data actual
petele reprezint doar 11% din hrana zilnic a omului.
Pn n prezent se cunosc cteva zeci de mii de specii de pete, care dup
mediul acvatic n care triesc se mpart n peti de ap dulce, peti marini i peti
oceanici.
Petii de ap dulce pot fi peti care se dezvolt i cresc natural n ape i peti de
[Link] marini i oceanici au ns ponderea cea mai mare sub raportul
speciilor i al cantitii pescuite.
esutul muscular al petelui sntos este lipsit de flora microbian, dar
contaminarea postmortem evolueaz foarte repede pornind de la flora microbian
din intestin i de la flora de pe suprafaa corpului dependent de microflora
bazinului acvatic habitat de pete.
Petele aparine produselor uor [Link] dup prindere, n esuturile
petelui ncep modificri fermentative sub influena bacteriilor psihrofile.
Flora microbian a petelui proaspt prins este reprezentat mai ales de bacterii
din genurile Pseudomonas, Achromobacter, Micrococcus, precum i de flora
halofil ca Vibrio parahaemolyticus.
n petele prins din ape impurificate se pot ntlni i reprezentani din familia
Enterobacteriaeceae ca [Link], Salmonella, Proteus.
Tema 14. Microflora petelui
[Link] produse n carnea de pete
La petele viu i refrigerat, controlul se execut la fiecare [Link] cel
conjelat, examenul se face pe loturi i se deschid 10% din ambalaje.
Examenul n general urmrete: integritatea, starea de sntate i flora de
prospeime.
Modificrile de natur [Link] pot avea ca principale
cauze: uneltele de pescuit, presiunea din lzile de transport, manipulrile
greite.n cadrul lor se nscriu: contuziile, soluiile de continuitate,
hemoragiile, rupturile abdominale cu eventraia viscerelor din cavitatea
[Link] leziuni trebuie extirpate fiind dezagreabile i constituind
principalele pori de intrare pentru microorganisme care vor da alterri.
Modificri [Link] boli infecioase ale petilor sunt:
Furunculoza. Este frecvent observabil la [Link] este
produs de Aeromonas salmonicida i se caracterizeaz prin prezena n
musculatur a unor pustule sangvinolente nsoite de ulceraii ale
[Link] abcese se gsesc profund n [Link] evolueaz i
cu enterit [Link] confisc petii cu abcese [Link] fac confiscri
locale, cnd leziunile nu sunt extinse iar carnea se d pentru prelucrare
tehnic.
Tema 14. Microflora petelui
Pesta roie a [Link] este produs de Bacterium cyprinidea i
se traduce prin apariia unor pete roii pe abdomen, lturile corpului,
aripioare i necroza [Link] intestinal prezint ulcere, iar
pericardul este [Link] cu letiuni ntinse i grave se
confisc.
Hidropizia infecioas a [Link] o boal care se manifest prin
balonarea abdomenului ca urmare a acumulrii de lichid n cavitatea
[Link] , ficatul i splina prezint leziuni [Link] se
observ ulcere i hemoragii ale [Link] nu se transmite la [Link]
confisc petii cu leziuni pronunate i cu modificri [Link] care
nu prezint modificri ale musculaturii se dau n consum.
Listerioza [Link] a fost semnalat n 1957 de Stamatin i
colab., fiind produs de Listeria [Link] se caracterizeaz
printr-un mare % al morbiditii i [Link] sunt depreciai i se
confisc.
Tema 14. Microflora petelui
3. Aprecierea prospeimii petelui.
Sub raportul prospeimii, petele poate fi: proaspt, relativ proaspt i [Link]
clasificare are n vedere caracterele organoleptice i condiiile fizico-chimice i
bacteriologice.
Din momentul prinderii pn la alterare, la peti se observ 3 faze succesive bine
distincte:
[Link] instalrii morii i a regiditii musculare.
Ea este precedat la nceput de o puternic secreie de mucus pe tegument, carev
constituie un mediu prielnic pentru dezvoltarea microbilor.
[Link] meninerii rigiditii musculare.n aceast faz se produc aceleai fenomene
ca i n carnea mamiferelor.
[Link] de [Link] se caracterizeaz prin dispariia rigiditii i nmuierea
[Link] i pierde elasticitatea, se accentueaz mirosul de pete i apoi apare un
miros neplut.n aceast stare, petele este impropriu pentru consum.
Procesul de autoliz se accentueaz i se ajunge la alterare.n ansamblu, alterarea se
desfoar dup aceleai procese biochimice i bacteriologice ca la carnea mamiferelor.
n aprecierea strii de prospeime a petelui se ine seama de regiditatea muscular,
aspectul ochilor i corneei, branhiilor, pielii, solzilor, anusului i viscerelor.
Petele conjelat se examineaz iniial n stare conjelat i apoi dup deconjelare.n
stare conjelat, petii care nu sunt proaspei au gura deschis, ochii nfundai n orbite,
iar solzii i pielea apar ntunecate.
Dup deconjelare se examineaz la fel ca i petele [Link] organoleptice
se completeaz cu examene fizico-chimice i bacteriologice.
Tema 14. Microflora petelui
4. Icrele
Icrele sunt ovulele nefecundate, recoltate n ultima faz a maturrii fiziologice, separate de regul de
esutul conjunctiv al ovarului.
Clasificarea lor se face dup mai multe criterii:
dup specie: se cunosc icre de peti comuni de ap dulce, de crap i tiuc; icre tarama ( amestec de
icre mici de la petii de ap dulce sau marini); icre de peti oceanici-cod, macrou, hering; icre de
sturion,morun, nisetru etc.
dup tehnologia de prelucrare se cunosc: icre conjelate i icre [Link] se face n raport de
prelucrare: cele conjelate , sub form de brichete, se ambaleaz n cutii de carton; cele srate n
butoaie de 15-50 kg; icrele negre ( caviar) n cutii metalice lcuite n interior, cu greutatea ntre 501000g.
Icrele sunt un aliment valoros prin coninutul ridicat n proteine, grsimi, sruri minerale i
[Link] alimentar nalt a icrelor este determinat i de faptul c ele se consum crude fr
a fi prelucrate termic.
Controlul icrelor se refer la: condiiile de prelucrare, condiiile de depozitare, examenul
organoleptic, fizico-chimic, bacteriologic.
La prelucrare se vor urmri condiiile de igien i respectarea tehnologiei de [Link] de
depozitare au o importan deosebit.n raport de felul conservrii se vor asigura anumite condiii de
pstrare.
Astfel, icrele conjelate se pstreaz la -16-20 C timp dr 6-7 [Link] srate de crap i stiuc se
pstreaz la maximum 5C timp de 3 luni cel [Link] tarama srate i maturate se pstreaz la 5C
cel mult 6 [Link] de Manciuria se pstreaz la maximum 5C timp de 4 [Link] se pstreaz n
ghea la 0-+2C maximum 25 zile.
Sub raport bacteriologic, icrele nu trebuie s conin germeni patogeni sau condiionat
patogeni.
Tema [Link] oulor
Structura i compoziia oului.
Prin ou, fr alt denumire, se neleg numai oule de gain.
Pentru celelalte ou se precizeaz specia de la care [Link] au o
valoare alimentar foarte deosebit prin compoziia lor [Link]
supuse influenei mediului prin pori, componenii oului snt ntr-o
continu [Link] este determinat i de complexitatea
i repartizarea neuniform a componenilor.
Cuticula oului este cea mai extern membran, fiind foarte fin, fiind
format din mucin i ovoporfirin.
Coaja este ataat la membrana cochilier prin mamilae emisferice
compuse din cristale de calciu.
Membrana cochilier extern este format din trei straturi de
mucin, iar memnbrana albuului dintr-un strat de keratune i unul de
[Link] glbenuului este la fel format din keratine i
mucine.
Albuul este structurat pe trei [Link] median este cel mai
vscos, pe cnd cel extern i perivitelinic este mai puin vscos.
Glbenuul este nvelit la exterior de membrana vitelin i conine
principii nutritive ce intervin n nutriia embrionului.
Prin compoziia sa, oul este un aliment complet, coninnd proteine,
grsimi, substane minerale, vitamine, enzime etc.
Tema [Link] oulor
Proteinele albuului snt:
Ovoalbumina, reprezint 50% din substana uscat a [Link] o fosfoprotein cu
1,8-2,8% polizaharid foemat din dou molecule de monoz i n rest de azot.
[Link] similar cu transferina sau cu beta proteina i are proprietatea
de a lega Fe, Cu i Zn n proporie de doi atomi pe molecul de [Link] aciune
antimicrobian fa de microorganismele care necesit fier pentru cretere i dezvoltare.
[Link] este o protein eterogen, fraciunile ei avnd un coninut diferit de
acid sialic.
[Link] este o globulin [Link] relativ stabil la cldur, frig i ali ageni, fiind
ns instabil la aciunea [Link] aciune enzimatic ca depolimerizator al
mucoproteinelor i activitate [Link] liza membranelor microorganismelor
gramnegative, deci posed activitate antimicrobian.
[Link] este puin cunoscut, nefiind obinut nc n stare [Link] gsete n
cantitate mai mare n stratul vscos al [Link] o mare capacitate de inhibare a
aglutinrii globulelor roii ale sngelui de ctre anumite virusuri.
[Link] din albu are ca grupare prostetic [Link] are proprieti
enzimatice, dar acioneaz ca agent de nglobare sau legare.
[Link] conine foarte multe [Link] proteic se numete [Link]
oului snt concentrate n [Link] rndul lor lipidele se mpart n: trigliceride,
fosfolupide, [Link] sunt reprezentate de lecitin, cefalin etc.
Tema [Link] oulor
8. Substanele minerale ale albuului snt n cantitate redus, ele gsinduse
concentrate n glbenu.n albu se gsete mai mult K, Na, Cl i mai puin Ca,
P, Fe. Glbenuul conine mult Ca, P, Fe i S i mai puin Na, Al, Zn, Mn,Cu,
Pb, Cl etc.
9. Vitaminele oului se gsesc n pondere mare n glbenu.n glbenu se
gsesc vitaminele complexului B i cele lipocolubile: A, D, E, [Link] lor
variaz n funcie de alimentaie i o suit de factori fiziologici.
[Link] oulor
Defectele oulor pot fi:
- originare sau ctigate
Ca defecte i anomalii originare se pot ntlni:
Anomalii i defecte ale cojii: ou fr coaj, ou cu coaj moale, ou cu
coaj subire, ou cu coaj neuniform, ou rugoase, ou cu coaj prea
[Link] ou se pot consuma fr a fi conservate. Consumul se face
imediat.
Defecte de form: ou mici, care se pot valorifica cnd provin de la ginile
tinere sntoase, ns nu se pot consuma fiind provenite de la gini bolnave;
ou alungite, ou rotunde, ou cu ambele capete groase.
Defecte de structur intern: ou fr glbenu care nu se comercializeaz;
ou fr albu care sunt mici i nu se comercializeaz; ou cu dou sau trei
glbenuuri- acestea sunt foarte mari, sunt comercializabile, dar nu se
conserv; ou cu snge; ou cu parazii care nu se comercializeaz, ou cu
corpi strini ( pietricele, pene, grune etc.) care nu pot fi consumate prin faptul
c sunt dezagreabile i contaminate cu bacterii.
Tema [Link] oulor
Printre defectele ctigate se nscriu:
Oule cu fisuri i [Link] apar la colectare, sortare, [Link]
pot consuma imediat sau se valorific prin melanj de ou.
Oule [Link] nu se preteaz pentru conservat i nu se pot
comercializa ca atare, ci cu grij deosebit se pot ntrebuina la prepararea
melanjului de ou, ct mai repede posibil.
Nu se admite splarea oulor murdare.
Oule [Link] i glbenuul oului snt dou sisteme coloidale
separate de membrana vitelin cu rezisten [Link] osmotic a
acestor dou sisteme este diferit i n ou exist un bogat echipament
enzimatic.n plus, cu toat prezena celor trei bariere protectoare a oului, oul
este permanent sub influena [Link] factorilor interni artai i
celor externi au ca rezultate finale modificri fizico-chimice i organoleptice n
ou, cunoscute sub denumirea de nvechire.
Una dintre cele mai precoce modificri este pierderea de ap din ou i
ptrunderea de aer. Scderea coninutului de ap din albu se face pe dou
ci: prin evaporare prin traversul cochiliei i migrarea unei pri n glbenu
prin [Link] efect al evaporrii apei, crete camera de aer i oul scade n
greutate. Ca efect al difuziunii apei n glbenu, acesta i mrete volumul.
Oule [Link] proces are loc cnd oule snt pstrate n condiii de
temperatur de peste 25C.n aceste cazuri n jurul discului germinativ se
observ o reea fin de capilare n forma unui inel rou i lichefierea albuului.
Tema [Link] oulor
[Link] oulor produse de microorganisme
Oule proaspete snt de obicei lipsite de microorganisme i opun o rezisten
natural temporar la ptrunderea i dezvoltarea germenilor microbieni n
coninut prin nveliurile de protecie ( cuticul, coaj i membranele cochiliere)
i proprietatea bactericid a albuului, datorit lizozimei i conalbuminei
.Cuticula, prin coninutul ei n mucin, are proprietatea bactericid, de aceea
manipulrile oulor trebuie s se fac cu grij ca membrana s rmn
[Link] i membranele cochiliere, dei poroase, opun o rezisten
mecanic pentru microorganisme, dar de nsemntate [Link]
provoac liza microbilor ce au ptruns n albu, iar conalbumina fixeaz fierul
i-l face indisponibil pentru bacteriile care au nevoie de el pentru cretere.
Glbenuul nu posed substane care pot s-i confere protecie fa de
microorganisme.
Cu tot acest echipament de protecie, n ou ptrund microorganisme, care vor
produce modificri ale [Link] oulor proaspete contaminate
n interior cu bacterii variaz ntre 2-5%, iar oue vechi ntre 10-15%.
Procesele biochimice iniiate de procesul de nvechire snt intensificate de
ctre microorganisme, ajungndu-se n final la alterarea [Link] intervenia
enzimelor proteolitice i aminoacidolitice, elaborate de microorganismele
ptrunse n ou, se produce hidroliza proteinelor din albu i glbenu, acestea
se lichefieaz i se amestec, iar oule iau aspect tulbure.n final, n ou apar
produi care modific compoziia i caracterele organoleptice, care confer
oulor un miros accentuat de putrefacie i le face improprii consumului i chiar
periculoase.
Tema [Link] oulor
n baza pigmenilor elaborai de ctre microorganisme se cunosc mai
multe tipuri de putrefacie: verde, neagr i roie.
Factorii care concur la alterarea putrific a oulor snt reprezentai
de : murdrirea oulor, umiditatea crescut i pstrarea la
temperaturi neadecvate.
Diversele tipuri de alterri snt legate de agentul microbiologic care a
poluat oul i de condiiile de pstrare.n cazul pstrrii oulor la
temperatura camerei, se dezvolt foarte bine genul Proteus, iar n
condiiile ostrrii oulor la rece-frigorifer- se dezvolt cele din genul
[Link] oulor cu germeni din genul Pseudomonas
este foarte grav, pentru c organoleptic se evideniaz foarte [Link]
pare evident dup 35 zile de pstrare la rece.
Putrefacia verde este n principal produs de germeni din genul
[Link] iau culoare verde, [Link]
ovoscopie nu se percep modificri n primele stadii.
Ulterior se produce lichefierea albuului care se coloreaz n verde i
eman un miros de varz alterat sau brnz.n stadiul final se
amestec albuul cu glbenuul i prin procese biochimice n ou apare
NH3, H2S, scatol, indol etc.
Tema [Link] oulor
Putrefacia neagr este produs prioritar de Proteus melanovogenes
n asociere cu [Link], Bacillus faecalis alcaligenes, Enterobacter
aerogenes [Link] se lichefiaz, se amestec cu glbenuul i iau
o culoare neagr sau [Link] au un miros penetrant.
Putrefacia roie este indus de unele genuri ca Sarcina i
Pseudomonas.
Putrefacia fecaloid sau gazoas este produs de Serratia
marcescens.n aceste cazuri, coninutul oului ia culoare
galbencrmizie, are aspect vscos i miros de brnz.
Se ntlnesc i alterri microbiene fr producere de pigmeni de ctre
microorganisme, asa cum se observ n cazul contaminrii oulor cu
[Link] [Link] bacterii coliforme dau miros de pete
[Link] perolens determin n ou miros de mucegai.
Mucegaiurile se pot dezvolta n [Link] diverselor specii de
mucegaiuri ptrund prin pori i si dezvolt miceliile n spaiul dintre
coaj i membrana cochilier, formnd [Link] examenul ovoscopic,
aceste ou apar [Link] miceilor favorizeaz ptrunderea
bacteriilor n interior.n oule contaminate cu mucegaiuri se percepe un
miros de mucegai, dup care se iniiaz procese de [Link] coaja
oulor au fost identificate micetele: Aspergillus flavus, [Link],
[Link]. Mucor globosus, Rhisopus niger, Candida albicans
etc.
Tema [Link] oulor
n ou n afar de flora bacterian saprofit, se pot ntlni i bacterii
[Link], avnd n vedere rspndirea la psri a
salmonelozelor i paratifozelor, n ou mai ales la rae se pot ntlni
germeni din genul [Link] oviduct sau cloac, oule pot fi
contaminate cu Mycobacterium avium.
4. Recoltarea, sortarea i examinarea oulor
Recoltarea oulor se efectueaz manual sau mecanizat trebuind s
evite: murdrirea, spargerea i [Link] se face des, i pn la
sortare oule se pstreaz n ncperi pn la [Link] murdare nu
se spal, deoarece se distruge cuticula.
Sortarea oulor pe categorii se efectueaz n funcie de greutate i
[Link] greutate, oule se mpart n . ou sub 40 g, ou mici
ntre 40-50 g i ou mari peste 50 [Link] sub 40g se livreaz la kg
ctre cantine, restaurante [Link] oulor dup greutate se face cu
ajutorul unor agregate.
Ambalarea oulor pentru consum se efectueaz n lzi de lemn sau
carton cu capacitate de 360-480 ou puse n cortaje de
[Link] oulor se face cu mare atenie, avnd n vedere
fragilitatea lor
Tema [Link] oulor
Examinarea oulor se poate face pe ou ntregi i pe ou [Link] oulor
ntregi cuprinde: examenul exterior, examenul ovscopic, densimetria etc.
Examinarea oulor prin metode ce necesit spargerea cuprinde: examenul organoleptic,
determinarea viscozitii albuului, determinarea puterii de cristalizare a ovalbuminei,
determinarea indecelui vitelinic [Link] mai utilizate metode de examinare snt
examenul exterior i ovoscopic.
n urma examinrilor fcute oule necorespunztoare se confisc i se distrug sau se
folosesc n scopuri tehnice.
Confiscarea se face n urmtoarele cazuri: oule cu hemoragii, cu corpi strini, cu
embrioni vizibili, cele ptate, mucegite, cele prea vechi, ru conservate i extrem de
murdare, cele putrefiate, ou la care sau identificat germeni patogeni extrem de
periculoi pentru om.
O problem aparte o constituie oule de [Link] chiar n stare proaspt
pot fi nocive, coninnd n ele germeni din genul [Link] interzice folosirea lor n
consumaie public la prepararea maionezelor, budincilor, salatelor etc.
Oule provenite din ferme de tuberculoz, se admit n consum numai dup o fierbere
de [Link] pot fi puse la incubat.
Oule provenite din focare de pseudopest vor fi dirijate n totalitate ctre consum
dup o prealabil dezinfecie n clorur de var 3%, timp de 15 minute.
Oule provenite din focare de holer aviar, se dirijeaz numai la consum dup o
prealabil dezinfecie n apa de var timp de 2-3 ore.
Oule provenite de la gini cu tifoz se admit n consum , dup o prealabil
dezinfecie n soluie de sod caustic 1% timp de 20 minute.
Tema 16. Microflora mierii de albine
1. Microorganismele din miere i aciunea bacteriostatic a mierii
n condiii normale, mierea conine un numr relativ redus de
microorganisme, reprezentate de bacterii, levuri i [Link]
microorganisme din miere i au originea n nectarul i polenul florilor
ca surse iniiale la care se adaug microorganismele de poluare
existente pe uneltele de lucru, aparatele folosite la obinere i recipieni
neigienizai.n acest sens nu trebuie neglijat nici aerul din spaiile de
prelucrare i igiena personalului de lucru.
[Link] cercetri mai vechi i mai noi, ncrctura bacterian
a mierii se situeaz sub 300 germeni/[Link], flora bacterian este
reprezentat n majoritate de bacterii sporulate din genul Bacillus
circa 86% i n mai mic msur de germeni nesporulai aparinnd
genurilor Micrococcus, Flavobacterium, Pseudomonas circa
14%.Bacteriile sporulate din miere nu germineaz, din cauza
concentraiei ridicate n glucide a substratului.
Se consider c sporii nu au nici o aciune asupra [Link]
patogene din familia Enterobacteriaceae, cu precdere Salmonella i
din familia Micrococcaceae, n special Staphylococcus aureus
enterotoxigen nu-i gsesc condiii favorabile [Link] toate
acestea, este prudent de a cerceta prin metode uzuale germenii care
reflect contaminri de origine enteric i ali germeni patogeni.
Tema 16. Microflora mierii de albine
Mierea are aciune antimicrobian care a fost observat i demonstrat prin
[Link] aciunii antimicrobiene sau bacteriostatice a mierii s-au emis mai
multe ipoteze.
Una din ipoteze explic aciunea bacteriostatic a mierii prin concentraia mare a
zaharurilor i acizilor organici, aciune combinat a enzimelor i zaharurilor i
componenilor substanelor [Link] de a doua ipotez, fr a exclude cea indicat
mai sus, arat c aciunea bacteriostatic a mierii este determinat de intervenia a doi
factori:
-inhibina Dold, substan bacteriostatic care se distruge prin tratare termic la 80C n
10 minute;
-una sau mai multe substane inhibitoare a dezvoltrii bacteriene care sunt solubile n
aceton, fotosensibile, [Link] substane, puin cunoscute, snt degradate n
extractele de miere de ctre razele ultraviolete n circa 10 minute.
Levurile.n miere se ntlnesc levuri n numr [Link] sunt reprezentate prioritar de
Saccharomyces melis i de [Link] levuri snt [Link] se poate
dezvolta cnd umiditatea mierii depeete 20%, iar secunda este capabil de
fermentarea zaharurilor n concentraie de 60% n substrat.
Aceste dou levuri snt capabile s produc fermentarea mierii.n condiii normale, n
miere, la examinarea sedimentului obinut prin centrifugare i executare de frotiuri
colorate, media numrului de levuri a zece cmpuri examinate nu va depi valoarea a
2-3 levuri.
n cazul prezenei levurilor n medie de 10 celule/cmp, mierea va fi considerat cu
conservabilitate limitat, recomandndu-se folosirea ct mai grabnic a acesteia n uniti
de patiserie.n cazul depistrii unui numr mai mare de 100000 levuri pe gram, mierea
se consider [Link] acestor microorganisme n miere influeneaz, n raport de
ncrctura lor, stabilitatea i calitatea igienic a produsului.
Tema 16. Microflora mierii de albine
Originea levurilor n miere se datorete ntroducerii lor de ctre albine
prin nectar i polen, dac aceast contaminare este limitat, tolerabil
i fr influene deosebite asupra produsului.
Contaminarea mierii cu levuri n cantitate mare se produce n spaiile
tehnologice de extracie i manipulare din aer, de pe utilaje,
instrumentar, recipieni neigienizai.
Miceii.n miere se pot dezvolta i unii micei filamentari ca
microorganisme osmofile i [Link] aerobe, acestea se dezvolt
la suprafaa mierii, mai ales cnd procesul de fermentare este iniiat de
ctre levuri.n aceste cazuri, miceii filamentoi se pot dezvolta pe
suprafaa [Link] tot timpul sporii produc miceliii.n cazul dezvoltrii
ei produc modificri de gust i miros, specifice procesului de
mucegire.
Cu toate c n miere s-a eveideniat i prezena unor micei toxigeni
cum ar fi Aspergillus flavus, toxigeneza este inhibat prin condiiile
oferite de substratul de dezvoltare.
Mierea normal va fi liber de bacterii patogene Salmonella,
Staphylococcus aureus enteroxigen sau alte bacterii care pot
provoca la consumatori tulburri [Link]
bacterian pe gram produs se va situa sub valoarea de 300 germeni/g
cu predominarea bacteriilor sporulate.
Tema 16. Microflora mierii de albine
Defecte, alterri i falsificri ale mierii
Principalele defecte ale mierii de albine snt reprezentate de:
- prezena impuritilor, consisten apoas, gustul amrui sau spirtos, caramelizare etc.
Ca alterri ale mierii se nscriu:
-fermentaia i mucegirea.
Mierea este un aliment care se preteaz la cele mai diverse falsificri directe pentru
corectarea gustului, consistenei, culorii, mpiedicarea fermentrii, neutralizarea aciditii,
corectarea sedimentului i echipamentului enimatic sau falsificri indirecte, prin hrnirea
albinelor cu strop de zahr.
Defecte ale [Link] din cele mai frecvente defecte ale mierii este prezena de
impuriti, reprezentate de fragmente de albine moarte, de ceruri sau alte impuriti
mecanice ( praf, nisip).Cauzele acestui defect nedorit este determinat de neglijene
tehnologice la [Link] cu astfel de defecte se poate comercializa dup
supunerea ei filtrrii sau altor operaiuni.
Mierea cu consisten apoas poate avea diferite [Link] proveni din cauza
recoltrii ei din faguri necpcii sau prin pstrarea n condiii necorespunztoare, mai
ales n spaii cu umiditate relativ [Link] miere necesit o valorificare ct mai
rapid.
Mierea caramelizat i are originea n tratare termic la temperaturi [Link]
caramelizat se claseaz la o categorie inferioar pentru livrare.
Mierea cu gust amrui, spirtos, astringent la fel se va declasa la o categorie de
calitate inferioar i se poate livra dac aceste defecte naturale i nu determinate de
adausuri prin falsificri.
Tema 16. Microflora mierii de albine
Pstrat n condiii necorespunztoare, mierea poate mprumuta diferite
mirosuri strine ( pete, brnz, petrol etc.), aprnd depreciat.
Alterri ale [Link] alterare a mierii rezid n fermentarea ei,
produs de [Link] cum sa prezentat anterior, procesul de fermentare este
determinat de Saccharomyces meli i [Link] cu precdere, dar pot
interveni ulterior i alte [Link] proces de fermentare se produce prin
modificri organoleptice de gust, miros, consisten, culoare.
Cu precdere la aceast miere, se percepe miros neplcut de fermentare
acetic, lactic, alcoolic sau chiar [Link] organoleptice snt
dublate de modificri fizico-chimice, privind umiditatea, aciditatea, densitatea
etc.
La mierea fermentat, examenul microbiologic va evidenia prezena levurilor
n numr mare.
Mucegirea mierii este alt proces de alterare care poate fi [Link]
contaminarea mierii cu micei i dezvoltarea lor la suprafaa produsului, i se
imprim acesteia gustul i mirosul de mucegai, fcnd-o improprie pentru
consum.
Falsificri ale [Link] este un aliment care se preteaz la cele mai
diverse falsificri, n scopul corectrii unor neajunsuri naturale privind gustul,
consistena, culoarea, aroma, aciditatea etc. sau al nglobrii n miere a unor
substane dulci, denaturnd produsul natural.
Orice adaus n mierea natural trebuie privit ca o falsificare; produsul
trebuie s fie livrat ctre consumatori n stare natural, dup obinere.
Tema 16. Microflora mierii de albine
Falsificrile mierii se pot grupa n:
-falsificri directe i indirecte.
Principalele falsificri directe se refer la:
-corectarea gustului prin adugarea de substane zaharate dulci
( zahr alimentar, zahr artificial, glucoz, melas) sau substane
ndulcitoare sintetice ( zaharin, glicerin, dulcine);
-corectarea consistenei prin adugare n miere de amidon, clei,
gelatin, gume, substane proteice;
-corectarea culorii prin adugarea de culori de anilin sau caramel;
-oprirea sau mpiedicarea fermentrii prin adugare de conservani
cu acidul benzoic i acidul salicilic;
-mascarea aciditii prin adugarea de substane neutralizante cu
hidroxid de sodiu, carbonat sau bicarbonat de sodiu;
-corectarea echipamentului enzimatic al mierii prinadugare de
extracie din culturi de drojdii sau din mal;
-corectarea sedimentului prin adugare de polen de flori, recoltat de
albine sau manual.
Falsificrile indirecte ale mierii de albine snt date de hrnirea
albinelor cu zahr sau sirop de zahr.
Tema 16. Microflora mierii de albine
[Link] mierii de albine
Acest control are n vedere cteva obiective i anume:
stabilirea calitii i puritii mierii;
stabilirea integritii, adic a falsificrilor;
aprecierea strii igienice privind deprecierea sau alterarea.
Pentru aceasta , laboratoarele snt obligate s execute un examen
organoleptic, fizico-chimic, microscopic al sedimentului i un examen
microbiologic.
Examenul organoleptic al mierii se refer la stabilirea corect a culorii, consistenei,
aromei, gustului, gradului de puritate.
Culoarea mierii se apreciaz corect la lumina zilei i numai pe miere
[Link] cristalizat se va fluidifica prin meninerea ei pe o baie de
ap la 45 C.
Coloarea la mierea de calitate superioar poate fi: aproape incolor (salcm),
galben-deschis, galben citron, galben aurie, galben portocalie, galben
verzuie, galben roscat, galben brun, brun.
La mierea de calitatea a 2-a, culoarea poate fi: galben nchis, brun deschis,
brun nchis, brun rocat, rubinie, verzuie.
Aroma perceput la mierea de calitate superioar este plcut i bine
[Link] mierea monoflor se va indica i denumirea speciei florale
predominante (salcm, tei, floarea soarelui etc.). Gustul acestei mieri este
plcut, dulce, [Link] mierea de calitate inferioar gustul este dulce, dar
aroma este mai slab exprimat.
Tema 16. Microflora mierii de albine
La aprecierea gustului se va cuta s se perceap unele
particulariti ca gustul spirtos, amrui, acrior, astringent etc., care pot
duce la declasarea calitii mierii cnd snt perceptibile uor.
Sub raportul consistenei, mierea se poate prezenta n stare fluid,
vscoas sau cristalizat, ct i dup fluidificare prin nclzire pe baie
de ap de 40-45C.
La mierea cristalizat se va stabili forma, mrimea i aspectul
cristalelor care pot fi: fine, nisipoase grosolane, untoase etc.
Puritatea mierii se apreciaz dup gradul de transparen a ei, prin
examinarea la lumina natural.
Examenul fizico-chimic al mierii urmrete stabilirea calitii i integritii
mierii.
Pentru aceasta se are n vedere stabilirea valorilor componenilor, identificarea
sau determinarea unor adausuri n scop de fraud-falsificare- i determinarea
unor produi rezultai din degradarea componenilor normali.
Mierea de consum trebuie s fie un aliment natural, fr nici un adaus.
Examenul microscopic al sedimentului mierii are importan ntruct pune n
eviden natura granulelor de polen i cantitatea lor, evideniaz numrul de
levuri pe cmpul microscopic i d relaii asupra puritii mierii sub raportul unor
corpi strini.
Tema 16. Microflora mierii de albine
Examenul microbiologic al mierii are n vedere flora microbian, levurile i
uneori miceii filamentoi.
Examenul microbiologic, att ca ncrctura microbian pe gram produs, ct i
examenul microbiologic calitativ privind bacteriile patogene pentru om se
execut la cerere i de necesitate, ori de cte ori se impune aceast situaie.
Examenul privind numrul de levuri pe cmpul microscopic sau pe gramul de produs d
relaii despre mierea care se va degrada n scurt timp i despre mierea deja fermentat.
Examenul pentru miceii filamentoi se impune de necesitate.
Msuri, sanciuni ce se iau dup examinare constituie meninerea calitilor nutritive,
dietetice i terapeutice ale mierii de albine se realizeaz prin pstrarea ei n condiii
corespunztoare.
Mierea se pstreaz n vase de sticl de culoare nchis sau n vase din material plastic,
acceptate sanitar, n spaii cu temperatura cuprins ntre 5-10C, umiditate relativ sczut,
aerisite corect, ferit de lumina solar direct.
Mierea care corespunde parametrilor organoleptici, fizico-chimici,
microscopici i microbiologici se admite n consum liber.
Mierea la care s-au identificat celule levuriforme fr modificarea peste limit a
aciditii i a celorlali parametri, se va da ct mai curnd n consum, avnd o
conservabilitate redus.
Mierea fermentat cu un coninut mai ridicat de levuri se scoate din consumul
uman, dnduise alte ntrebuinri tehnologice.
De asemenea se scoate din consum uman mierea care conine flor patogen,
micei filamentoi care au produs modificri organoleptice sesisabile.
Tema 17. Microflora conservelor
[Link] conservelor cu microorganisme.
Se caracterizeaz prin diverse bombaje:
- fizice, chimice i microbiologice.
Cele fizice i chimice snt rar ntlnite la semiconserve, dac se respect strict
tehnologia de fabricaie.
Bombajele microbiologice snt dependente de :
ncrctura bacteriologic iniial a crnii i materiilor auxiliare;
Condiiile igienice pe fluxul tehnologic;
Condiiile de pstrare numai la rece;
Nivelul termic asigurat n centrul conservei i termorezistena microflorei din produs.
Bombajele semiconservelor snt produse de bacterii anaerobe din genurile
Clostridium i Bacillus i unele bacterii facultativ anaerobe cu producere de
gaze.n semiconserve se pot ntlni dou categorii de bacterii: netolerabile i tolerabile.
Bacteriile netolerabile se pot mpri n trei grupe:
A) grupa bacteriilor patogene cu semnificaie epidemiologic mare, n care se
cuprind Salmonella, [Link] enterotoxigen, [Link] i [Link];
B) grupa bacteriilor posibil patogene, cu semnificaie epidemiologic relativ, dar
cu pronunat caracter proteolitic.n aceast grup intr: [Link], [Link],
Streptococcus, Bacillus subtilis, Bacillus cereus, [Link], Enterobacter, Proteus.
C) grupa bacteriilor fr semnificaie epidemiologic, dar puternic proteolitice, care
cuprinde: Alcaligenes, Flavobacterium, Pseudomonas, Micrococcus, Lactobacillus,
[Link].
Tema 17. Microflora conservelor
Bacteriile tolerabile snt inactive fa de proteine i inofensive pentru
om.n ele se cuprind bacterii din genurile Bacillus i Clostridium.
n baza cercetrilor actuale s-a propus ca semiconservele sa se
caracterizeze prin:
Absena din coninut a germenilor patogeni Clostridium botulinum i
toxina sa Salmonella, Shigella, [Link], [Link];
Absena microorganismelor capabile s altereze produsul ( unele
specii de Ba cillus, Micrococcus, Corynebacterium, streptococi,
Lactobacillus);
Absena bacteriilor care denot defecte de prelucrare i neermeticitate
( Alcaligenes, Pseudomonas, Flavobacterium, levuri, mucegaiuri );
Tolerarea celorlalte grupe de bacterii, ca specii inerte de Bacillus i
Clostridium, adic nepatogene, netoxigene, nedetrifiante, negazogene
i incapabile s altereze produsul.
Pe baza acestor date, fiecare ar i-a elaborat normative proprii.
Tema 17. Microflora conservelor
[Link] conservelor
Bombajele microbiologice ale semiconservelor snt induse
cu precdere de bacterii din genurile Clostridium i
Bacillus.
Clostridiile intervin mai rar, datorit pstrrii
semiconservelor la rece i adugri n produs a NaCl,
nitrii, polifosfai.
Genul Bacillus este proteolitic i zaharolitic i produce
adesea modificri aloe semiconservelor. La fel deseori
produc alterri ale conservelor: [Link], [Link],
[Link].
Pot produce alterri streptococii din grupa D, care snt
termorezisteni, au proprieti proteolitice i zaharolitice.
Alterrile sunt produse de microorganisme foarte variate i
aparin prioritar bacteriilor psihrotrofe, se dezvolt la
temperaturi de refrigerare ca Pseudomonas,
Enterobacter, Acinetobacter, [Link] participa
la alterare i alte microorganisme saprofite i patogene.
Tema [Link] alimentare
[Link] alimentare produse de speciile Salmonella i Shigella.
Una din problemele importante care preocup specialitii din domeniul sntii
publice este i aceea a toxiinfeciilor alimentare.
Prin activitatea de prevenire a bolilor infecioase, transmisibile la om i prin cea
de control sanitar-veterinar al produselor de origine animal, medicul veterinar
este unul din factorii de baz n combaterea zoonozelorr i n prevenirea
ajungerii n alimentaia omului a produselor de origine animal.
Toxiinfeciile alimentare snt ncadrate n categoria strilor morbide
explozive ale tubului digestiv, n urma ingestiei de alimente.
Se neleg prin intoxicaii alimentare acele stri morbide, rezultate din
ngerarea unor alimente care conin anumite substane toxice.
Toxiinfeciile alimentare snt definite ca stri morbide dfigestive cu caracter
exploziv, cauzate de ngerarea unor alimente contaminate cu bacterii cu
produii lor de metabolism.
Natura microbian a acestor tulburri le imprim dou caracteristici eseniale:
-apariia exploziv a bolii la grupe de indivizi;
-tulburri gastrointestinale cu evoluie acut dup o perioad de incubaie
scurt.
Toate tulburrile digestive explozive i perioada de incubaie scurt,
provocate de alte cauze dect microbian, se definesc ca intoxicaii alimentare.
Tema [Link] alimentare
Toxiinfeciile alimentare se clasific dup dou elemente de baz:
agentul infecios i patogenitate.
Dup caracterul principal de patogenitate al agentului etiologic,
toxiinfeciile alimentare se pot clasa n:
- toxiinfecie alimentar de tip infecios i de tip toxic.
Tipul infecios este determinat de nmulirea n organismul bolnavilor
a bacteriilor ntroduse odat cu [Link] tip de toxiinfecie se
caracterizeaz printro incubaie de 8-24 ore, iar clinic se traduce prin
febr, cefalee, greuri, vrsturi, colici abdominale, diaree, urmat
uneori de moartea bolnavului.n acest grup de toxiinfecii se nscriu
cele determinate de Salmonella, Shigella, [Link].
Tipul toxic de toxiinfecie alimentar este determinat de absorbia
toxinei elaborate de microorganisme n substratul alimentar
[Link] tip de toxiinfecie alimentar este determinat de o
incubaie scurt de 1-6 ore, lipsa strii febrile, diarree profuz, vomitri
violente, durata de evoluie de 24 ore, excepuie face toxiinfecia
produs de Clostridium botulinum.
Tipul toxic este produs de bacterii patogene ca [Link],
[Link], Staphylococcus aureus, dar i de bacterii
condiionat sau potenial patogene ca [Link], Proteus, [Link]
etc.
Tema [Link] alimentare
Etiologia toxicoinfeciilor alimentare se stabilete pe baza simptomatologiei, evoluiei bolii i datele
[Link] asemenea n cazul unor toxicoinfecii alimentare ca cea produs de
[Link], simptomatologia specific i aciunea toxinei snt elemente suficiente de diagnostic.
ntre toxicoinfeciile alimentare produse de de diveri germeni pe primul loc se situeaz
toxicoinfeciile produse de [Link] primul loc se afla specia Salmonella typhimurium dup
care urmeaz: [Link] suis, [Link], [Link] etc.
Carnea poate fi contaminat intravital iar mbolnvirile la om se produc n urma consumului de
carne.
Carnea poate fi contaminat i post-mortal, dup obinere prin contact direct cu crnuri infectatwe,
prin manipulri etc.
Alt surs de infecie a omului o constituie oule, cel mai frecvent cele de ra i gsc, care pot
conine salmonele att n interior ct i pe coaj.
Laptele i produsele lactate pot fi contaminate cu salmonele transmind bola la [Link] poate
fi contaminat n timpul transportrii, recoltrii, prin poluare cu materii fecale de la animalele bolnave
sau purttoare etc.
Laptele praf poate si el constitui surse de contaminare a [Link] a fost i ea incriminat
n producerea tociinfeciei alimentare.
Pstrarea alimentelor de orice natur la temperatura ambiental creaz condiii de multiplicare a
salmonelelor. Aa de exemplu, pstrarea oulor la temperatura de 18-25C timp de 2-5 zile d
posibilitate salmonelelor din coninut s se nmuleasc n numr foarte mare i s induc
toxiinfecia sever.
Bacteriile din genul Shigella snt imobile i posed numai antigen [Link] cuprinde patru specii
care posed antigeni specifici somatici O, pe baza crora snt mpriti n subgrupe i serotipuri.
Bacteriile din acest gen pot determina toxiinfecii alimentare i dizenteria bacilar cronic.
Tema 16. Microflora mierii de albine
Tema 16. Microflora mierii de albine
Tema 16. Microflora mierii de albine
Tema 16. Microflora mierii de albine
Tema 17. Microflora conservelor
Tema 16. Microflora mierii de albine
Tema 16. Microflora mierii de albine
Tema 16. Microflora mierii de albine
Tema [Link] oulor
Tema 17. Microflora conservelor
Tema [Link] oulor
Tema 16. Microflora mierii de albine
Tema [Link] oulor
Tema 16. Microflora mierii de albine
Tema 16. Microflora mierii de albine
Tema 16. Microflora mierii de albine
S-ar putea să vă placă și
- Prezentare Curs 3 Microorganisme in Produsele Alimentare100% (3)Prezentare Curs 3 Microorganisme in Produsele Alimentare22 pagini
- Area Alimentelor Cu Microorganisme-Bacterii Final 1100% (1)Area Alimentelor Cu Microorganisme-Bacterii Final 18 pagini
- Metode Moderne de Control Micro Biologic Al Alimentelor100% (1)Metode Moderne de Control Micro Biologic Al Alimentelor18 pagini
- Efectul Factorilor Biologici Asupra Inocuităţii Produselor AlimentareÎncă nu există evaluăriEfectul Factorilor Biologici Asupra Inocuităţii Produselor Alimentare54 pagini
- Tehnici Avansate de Analiză Și Expertizare - Proiect - SAPCCPA Anul IÎncă nu există evaluăriTehnici Avansate de Analiză Și Expertizare - Proiect - SAPCCPA Anul I28 pagini
- Importanta Microorganismelor Pentru Calitatea Nutritiva Si Sanitara A AlimentelorÎncă nu există evaluăriImportanta Microorganismelor Pentru Calitatea Nutritiva Si Sanitara A Alimentelor4 pagini
- Infectarea Cu Microorganisme in Industria AlimentaraÎncă nu există evaluăriInfectarea Cu Microorganisme in Industria Alimentara6 pagini
- Infectarea Cu Microorganisme in Industria AlimentaraÎncă nu există evaluăriInfectarea Cu Microorganisme in Industria Alimentara7 pagini
- 41.rolul Diferitor Alimente La Isbucnirea Intoxiinfecțiilor Alimentare Cu Micribi Potențial Patogeni, Epidemiologia, ProfilaxiaÎncă nu există evaluări41.rolul Diferitor Alimente La Isbucnirea Intoxiinfecțiilor Alimentare Cu Micribi Potențial Patogeni, Epidemiologia, Profilaxia18 pagini
- Posibilitati de Contaminare Microbiologica A AlimentelorÎncă nu există evaluăriPosibilitati de Contaminare Microbiologica A Alimentelor9 pagini
- Note de Curs La Microbiologia AlimentaraÎncă nu există evaluăriNote de Curs La Microbiologia Alimentara136 pagini
- Interrelaţii Ecologice Aliment-MicroorganismÎncă nu există evaluăriInterrelaţii Ecologice Aliment-Microorganism33 pagini
- Studiu Bibliografic "Bacterii Coliforme - E.coli": Nume Simion Ana-Maria Grupa 4204 Specializare TPPAÎncă nu există evaluăriStudiu Bibliografic "Bacterii Coliforme - E.coli": Nume Simion Ana-Maria Grupa 4204 Specializare TPPA15 pagini